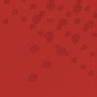

Magazine
Le mensuel de l’entrepreneur et de l’installateur Une publication d'Embuild • Avenue des Arts 20, 1000 Bruxelles • Bureau de dépôt Gent X • €6
DOSSIER : L’ATTRACTIVITÉ

Le mensuel de l’entrepreneur et de l’installateur Une publication d'Embuild • Avenue des Arts 20, 1000 Bruxelles • Bureau de dépôt Gent X • €6
DOSSIER : L’ATTRACTIVITÉ

LOBBYING
Embuild rencontre Thomas Dermine sur un chantier phare wallon
PRIME POUVOIR D’ACHAT Un « petit extra » pour les travailleurs
RENOLUTION
La stratégie de rénovation du bâti bruxellois va créer 8.000 emplois









































































Notre secteur connaît actuellement des turbulences. Surtout dans le domaine de la construction résidentielle et de la rénovation. L’augmentation des prix des matériaux et des salaires y est pour beaucoup, mais aussi le taux d’intérêt hypothécaire, qui a été multiplié par quatre à court terme. Cette évolution est tout à fait pernicieuse pour les consommateurs qui souhaitent construire ou rénover.
Heureusement, les travaux d’infrastructure, stimulés par les plans de relance et les élections communales d’octobre 2024, se portent très bien et maintiennent globalement la construction à flot, sinon le tableau de la construction serait tout rouge. Mais qu’en sera-t-il après 2024, lorsque les plans de relance s’estomperont petit à petit et que les élections seront passées ? Nous craignons que la situation se complique pour cette branche de la construction.
Nous constatons également que la croissance des entreprises dans le secteur a pratiquement stagné au cours des six premiers mois de cette année. Le nombre de créations d’entreprises a diminué de 2 % par rapport au premier semestre 2022, tandis que le nombre de cessations d’activité (+ 16%) et le nombre de faillites (+ 7%) ont également continué d’augmenter. Il s’agit en partie d’une correction logique après les nombreuses créations d’entreprises dans le secteur au cours des années de crise sanitaire. Mais les prochains mois révèleront s’il existe également des problèmes structurels sous-jacents.
Le fatalisme n’a jamais porté ses fruits. C’est pourquoi Embuild met toute son
énergie à essayer de renverser la vapeur et de convaincre les décideurs politiques des différentes mesures nécessaires. En septembre, nous avons visité le chantier du nouvel hôpital de Tournai avec le Secrétaire d’Etat à la Relance Thomas Dermine et insisté sur la nécessité de porter les investissements publics, actuellement de 2,7% du PIB, à 4% du PIB d’ici 2029. Le secrétaire d’état était tout à fait sur la même longueur d’onde, nous-a-t-il dit. Il est aussi conscient qu’il n'y a pas d’autre solution pour faire entrer enfin dans le XXIe siècle nos infrastructures, aujourd’hui largement vétustes.
Une autre question épineuse continue de dominer l’ordre du jour : la prolongation de la TVA réduite sur les démolitions-reconstructions. Cette mesure, sauf dans 32 centres urbains, expire à la fin de cette année. À moins que le gouvernement fédéral en décide autrement. Embuild continue son lobbying pour que cette mesure devienne permanente.
Elle est bonne pour notre secteur, mais plus important encore, elle est positive pour les consommateurs et pour répondre à l’obligation européenne des logements neutres en carbone d’ici 2050. Nous n’atteindrons pas du tout ce standard sans les démolitions-reconstructions, les trois quarts des logements ayant été construits à une époque où les normes énergétiques n’existaient pas. Notre secteur peut faire évoluer les choses, mais cela nécessite des mesures de soutien telles que cette réduction de la TVA sur les démolitions-reconstructions.
Niko Demeester CEO Embuild« Le fatalisme n’a jamais porté ses fruits. C’est pourquoi Embuild met toute son énergie à essayer de renverser la vapeur et de convaincre les décideurs politiques des différentes mesures nécessaires. »

Il est urgent d’inverser la tendance pour éviter une
3 ● Édito

Il est urgent d’inverser la tendance pour éviter une crise profonde dans le résidentiel.
7 ● Point de vue régional
ChatGPT, la blockchain et l’omniverse.
8 ● Présidence Embuild
Christophe Maes va succéder à Thomas Scorier.
10 ● Matexpo
Le semi-remorque Vogelzang remporte le Safety Award.
VOS INTÉRÊTS
14 ● Prime pouvoir d’achat
Un « petit extra » pour les travailleurs.
16 ● Indemnité vélo

Les réponses à vos questions.
DOSSIER
19 ● Introduction
L’attractivité des emplois.
20 ● Emploi des ouvriers
Le flux entrant est sous pression.
24 ● Embuild Wallonie
L’entité régionale multiplie les initiatives pour rendre les jobs attractifs.



26 ● Embuild.Brussels
La construction bruxelloise a besoin de 1.000 nouveaux entrants par an d’ici 2030.
UN « PETIT EXTRA » POUR LES TRAVAILLEURS
Les entreprises, qui ont réalisé un certain bénéfice en 2022, devront accorder une prime pouvoir d’achat unique à leurs travailleurs d’ici la fin de l’année. Les accords sectoriels conclus fin juin pour les travailleurs du secteur de la construction (CP 124 et CP 200) fixent les critères d’octroi et les montants de la prime. Ceux-ci sont très différents pour les ouvriers et les employés.
DOSSIER : L’ATTRACTIVITÉ DES EMPLOIS


Le marché du travail est sous pression dans la construction. La pénurie de main-d’œuvre est une priorité pour Embuild dans le message que nous adressons au monde politique, en vue des élections de 2024. La fédération professionnelle multiplie les initiatives pour rendre les emplois attractifs dans le secteur.

EMBUILD RENCONTRE THOMAS DERMINE SUR UN CHANTIER PHARE WALLON
Le 5 septembre dernier, Embuild a visité le chantier du nouvel hôpital de Tournai (CHwapi), en compagnie de Thomas Dermine, le Secrétaire d’Etat pour la Relance et les investissements stratégiques. Notre CEO Niko Demeester a profité de l’occasion pour insister sur l’importance d’un plan d’investissements pour les années à venir. « Les investissements publics ne doivent pas diminuer après les élections de 2024, ils doivent atteindre les 4 % du PIB d’ici la fin de la prochaine législature en 2029 », a-t-il indiqué.

SECTEURS & MÉTIERS
28 ● Lobbying
Embuild rencontre Thomas Dermine sur un chantier phare wallon.
30 ● Renolution
La stratégie de rénovation du bâti bruxellois va créer 8.000 emplois.
32 ● Community Land Trust Bruxelles
Objectif : création de logements abordables.
34 ● Groupe Jean Nonet
L’entreprise reprend Guisse & Fils.
36 ● Rapport Buildwise
La ‘Guerre des talents’ est une mégatendance.
38 ● Buildwise
• Innovation Paper 41 de Buildwise : systèmes de ventilation innovants pour les logements en rénovation.
• Nouvelle NIT 287 sur la stabilité des machines de fondation.
PROJETS & ENTREPRISES
42 ● Projet
Le CHU de Liège triple sa capacité de places de parking.
46 ● Avantages membres
Votre affiliation se rentabilise.
49 ● Marché de la construction
LE CHU DE LIÈGE TRIPLE SA CAPACITÉ DE PLACES DE PARKING
Le problème de stationnement est récurrent depuis des années aux alentours du CHU de Liège, sur le site du Sart Tilman. Avec la construction de trois nouveaux parkings, triplant presque la capacité d’accueil de véhicules, ce problème est désormais résolu après environ trois ans de travaux. Embuild Magazine a visité le site, avec notre membre eloy, la cheville ouvrière de ce projet.

• ABAX
• Knauf Tools
50 ● Marquant
• EuroSkills Gdansk
• Chiffre du mois




















Le secteur de la construction se numérise avec des innovations majeures dans tous les segments de la chaîne de valeur. Tant en phases de conception et de construction qu'en phases d'exploitation des bâtiments et de leur fin de vie. La numérisation est un levier majeur pour travailler de manière plus efficace et orientée client. Les logiciels de gestion, la robotisation, l’automatisation, les scanners 3D et les drones permettent d’augmenter la productivité. Pour cela, un changement profond dans la gestion des entreprises est nécessaire. Embuild et Buildwise vous guident et vous accompagnent à travers ces évolutions souvent disruptives..
La blockchain et l’intelligence artificielle (IA) offrent de nouvelles perspectives inédites. Une blockchain permettra ainsi de gérer les relations entre les différents intervenants via des smart contrats. Ceux-ci permettront notamment de mieux gérer le cash-flow. Depuis l’avènement de ChatGPT, l’IA se répand comme une traînée de poudre. À l’avenir on peut imaginer qu’une IA s’assure de la conformité d’un projet au permis de bâtir ou son alignement par rapport à la taxonomie européenne. Le permis, lui-même, aura été introduit via BIM et aura fait l’objet d’un contrôle de conformité quasi instantané par l’administration via l’IA, avec toutes les conséquences positives au niveau de la transparence et de la réduction des délais de délivrance. L’innovation connaîtra peu de limites : la société NVIDIA vient de créer une plateforme omniverse pour créer un jumeau numérique de la planète.
Mais une IA ne sera aussi performante que sur les textes avec lesquels elle a été entraînée. OSIRIS est ainsi le contre-exemple
de l’augmentation de la productivité liée à la numérisation. Des textes de base complexes et contraignants et une administration tatillonne ont fait de cette application le cauchemar quotidien de nombreux entrepreneurs.
À Bruxelles, la législation et la réglementation urbanistiques sont d’une complexité sans précédent. Des textes sur différentes couches de compétences, avec des prescriptions permettant des interventions humaines dérogatoires et un phénomène BANANA (Build Absolutely Nothing Anywhere Near Anything), donneront des résultats peu probants avec l’IA. Il est impératif et urgent de revoir les textes de base et de les simplifier.
À moins de partir d’une feuille blanche et de demander à ChatGPT de les réécrire en se basant sur les meilleures pratiques en vigueur.
Jean-Christophe Vanderhaegen Directeur Général Embuild.Brussels Vlaams-Brabant

« La blockchain et l'intelligence artificielle (IA) offrent de nouvelles perspectives inédites. »

Le 13 septembre dernier, le Conseil national d’Embuild d’Embuild a élu Christophe Maes, administrateur délégué de Messiaen, comme President elect d’Embuild. Il succédera à Thomas Scorier, administrateur délégué de TS Construct, comme président d’Embuild en mars 2024.
Christophe Maes, entrepreneur né et auparavant président d’Embuild Vlaanderen, se réjouit déjà de relever ce défi. « La construction se retrouve face à de nombreux défis, et je souhaite m’y investir à 100 %. Par exemple, nous devons veiller à ce que la construction et la rénovation restent abordables, que les investissements publics dans les infrastructures augmentent fortement, que nous puissions faire face à la pénurie de main-d'œuvre et que nous préparions la construction pour l'avenir, notamment grâce à la numérisation et à la standardisation. Il y a beaucoup de pain sur la planche, en d'autres termes, c’est à cela que je veux m’employer avec Embuild. »
Christophe Maes a 62 ans, est père de 3 enfants, quatre fois grand-père, et habite à Gand. Il est administrateur délégué de Messiaen SA, une entreprise de construction spécialisée principalement dans la rénovation, la réhabilitation et l’entretien constructif, qu'il dirige avec son fils Olivier. Il deviendra président d’Embuild en mars 2024. Il travaillera dès maintenant aux côtés de l’actuel président Thomas Scorier et du CEO Niko Demeester.
Le futur président d’Embuild a commencé sa carrière dans la construction avec son père Roland, son frère Tony et sa sœur Sophie dans l’entreprise familiale Maes, dont il est toujours administrateur aujourd'hui. Il est également actif chez Embuild depuis de nombreuses années. Il a été président d’Embuild Vlaanderen de 2012 à 2015, et a présidé la FEGC, la Fédération des Entrepreneurs Généraux de la Construction, de 2015 à 2018. Il a été administrateur d’Embuild de 2003 à 2023, et membre depuis 2002 du Conseil national d’Embuild.
Thomas Scorier, président d’Embuild, se
réjouit de cette nomination. « Christophe est le candidat idéal pour reprendre la présidence d'Embuild. Ses années d'expertise au sein du secteur de la construction et de notre organisation professionnelle nous permettront de peser encore plus lourd sur la société et sur l’économie dans les années à venir. Christophe connaît très bien notre secteur sous tous ses aspects, et il est actif dans diverses branches de notre fédération professionnelle depuis des années. On ne pouvait pas trouver meilleur candidat. »
"La construction se retrouve face à de nombreux défis, et je souhaite m'y investir à 100 %."
Rendez-nous visite à Bruxelles, à Court-Saint-Étienne et à Liège.
Découvrez notre assortiment complet également en ligne : www.clabots.be




L’édition 2023 de Matexpo s’est terminée le dimanche 10 septembre, à Courtai Expo. En tant que partenaire structurel de l’événement, Embuild y a organisé de nombreux séminaires et a accueilli du monde sur son stand. Notre CEO, Niko Demeester, a également remis le Safety Award lors de la soirée d’inauguration, en présence de 500 invités.
Améliorer la sécurité sur chantier est l’une des nombreuses priorités d’Embuild. Le lancement de notre campagne Safety My Priority, il y a quelques années, en est bien la preuve. C’est donc notre fédération professionnelle, via les mains de son administrateur délégué, qui a remis le Safety Award lors du salon professionnel bisannuel des machines et du matériel pour la construction.
« La sécurité est primordiale pour Embuild et pour l’ensemble du secteur de la construction. La construction a la réputation d’être un secteur peu sûr. Néanmoins, le nombre d’accidents de travail dans le secteur diminue d’année en
année », a souligné NIKO DEMEESTER , le CEO d’Embuild. « Et pourtant, nous n’y sommes pas encore. C’est pourquoi Embuild est un fervent défenseur d’une plus grande sécurité dans la construction. Nous avons donc lancé notre propre plan de sécurité. Entre-temps, une mesure importante de ce plan a déjà été réalisée : depuis le 15 avril, tous les nouveaux travailleurs, indépendants et détachés opérant sur des chantiers doivent suivre une formation de base obligatoire en matière de sécurité de huit heures. »

D-Tec Trailers Benelux
Cette année, c’est le semi-remorque
« La sécurité est très importante, tant dans notre production que dans nos ateliers, et cette méthode de travail est largement soutenue par tous nos collaborateurs. »
STEF VOGELS
Vogelzang de D-TEC Trailers Benelux, qui a remporté le prix. Il s’agit d’une remorque à pierres, existant en trois tailles, qui ne nécessite plus l’arrimage de la charge par des sangles. Après avoir effectué des tests physiques sur le hayon, les ridelles, les crics Kinnegrip et une grue mobile Hyva/Kennis, la TÜV (l’autorité de contrôlé allemande) a approuvé la combinaison comme ayant une sécurité de chargement jusqu’à 35 tonnes de charge utile. Le certificat s’applique aux remorques de 12m85 et 13m15 avec des ridelles de 1 ou 1m20 de hauteur. « Grâce à ce certificat, le conducteur ne doit plus sécuriser son charge-
ment lorsqu’il est chargé en position fermée, du becquet frontal à l’arrière de la grue. Cela signifie donc que, si un chargement est fermé et qu’il n’y a pas d’espace entre les palettes, le chauffeur ne doit plus sécuriser. C’est le plus important et c’est possible jusqu’à 35 tonnes », a expliqué STEF VOGELS , account manager chez D-TEC Trailers Benelux.
Il y a deux ans, D-TEC Trailers Benelux, basé aux Pays-Bas, a commencé à proposer la vente de ses produits via son propre rayon d’importation, avec son équipe de ventes en Belgique et quelques revendeurs. « Ces deux dernières années, nous nous sommes surtout concentrés sur nos châssis de citernes et de conteneurs. Désormais, nous élargissons notre champ d’action pour entrer dans l’industrie de la construction, avec nos semi-remorques et nos remorques plateformes. Par conséquent, Matexpo, en tant que salon de premier plan du secteur de la construction, était très important pour nous, afin de faire connaître notre marque et nos remorques à de nombreux clients potentiels dans toute la Belgique », a indiqué l’account manager.
À l’heure du bilan, les organisateurs se montraient satisfaits de cette 40 e édition qui s’est déroulée, la plupart du temps, sous un soleil radieux. « Malgré un climat économique incertain, 38.048 visiteurs ont répondu présents, avec cette année un accent mis sur la jeunesse. Le soleil et les températures tropicales n’ont pas joué les trouble-fêtes, bien au contraire : les intéressés et les passionnés trouvent toujours le chemin de ce salon. Et pour les 357 exposants, l’essentiel est de nouer des contacts de qualité. Presque tous les exposants sont d’accord sur un point : la qualité des visiteurs était particulièrement élevée cette année. Cela a donné lieu à de nombreux contacts, à de bonnes pistes et, pour de nombreux exposants, à des ventes concrètes. Cette année, il convient aussi de souligner le taux de participation exceptionnellement élevé aux nombreux séminaires et activités parallèles », ont écrit les organisateurs dans un communiqué.
Par ailleurs, le directeur GREGORY OLSZEWSK i, tenait aussi à souligner la bonne collaboration avec Embuild. « Je pense que l’on ne peut organiser ce type de salon que si toutes les parties prenantes du secteur y participent. Vous avez besoin d’un partenariat solide. Dans le cas d’Embuild et de Matexpo, il est très solide et s’est développé historiquement. C’est très important parce que vous pouvez alors être sûr que vous atteignez toutes les personnes actives dans ce secteur d’une manière ou d’une autre », a-t-il indiqué.
Le directeur et son équipe vous fixent déjà d’ores et déjà rendez-vous pour la 41 e édition de Matexpo, qui aura lieu du 10 au 14 septembre 2025.
Stef Vogels était bien évidemment heureux d’avoir reçu ce prix et remerciait au passage toutes les équipes de D-TEC Trailers Benelux. « Nous sommes extrêmement fiers d’avoir remporté le Safety Award. En effet, beaucoup de gens dans notre entreprise ont travaillé très dur : ingénieurs, dessinateurs, chefs de produit, mais aussi les personnes de la production qui se démènent chaque jour pour construire et livrer à nos clients des remorques de la meilleure qualité possible. En bref, tous les collaborateurs de notre entreprise sont très fiers de recevoir ce prix. En tant que Groupe Vlastuin, nous construisons environ 2.000 remorques par an. La sécurité est très importante, tant dans notre production que dans nos ateliers, et cette méthode de travail est largement soutenue par tous nos collaborateurs. Associer la sécurité à la rapidité, afin d’accroître l’efficacité de nos clients, s’inscrit parfaitement dans notre culture d’entreprise », a-t-il expliqué. Outre le Safety Award, deux autres prix ont été remis. L’Innovation Award a récompensé le HiSPS de Wolffkran qui est distribué dans notre pays par Verhelst Machines. Il s’agit d’un système de contrôle de position du crochet de grue sur une grue à tour. Et Locquet Power & Light a reçu le Green Award pour son volant d’inertie P200 développé par Punch Flybrid.






Là où il y a de la place pour une fenêtre de toit, il y en a souvent pour plusieurs.
• 1 seul cadre, 2 ou 3 fenêtres pour plus de lumière naturelle


• Installation facile grâce au châssis fixe amovible



• Meilleur rapport qualité-prix que des fenêtres individuelles de même taille


Disponibles en plusieurs dimensions, manuelles ou motorisées 3en1

2en1

Plus d’infos





Les entreprises, qui ont réalisé un certain bénéfice en 2022, devront accorder une prime pouvoir d’achat unique à leurs travailleurs d’ici la fin de l’année. Les accords sectoriels conclus fin juin pour les travailleurs du secteur de la construction (CP 124 et CP 200) fixent les critères d’octroi et les montants de la prime. Ceux-ci sont très différents pour les ouvriers et les employés.
La norme salariale, qui est déterminée tous les deux ans en fonction de l’évolution des salaires dans nos pays voisins, est égale à 0 % pour la période 2023-2024. Cela signifie qu’en dehors des indexations, les travailleurs ne peuvent normalement pas bénéficier de nouvelles augmentations de salaire ou d’avantages. Néanmoins, au-delà de cette marge, le gouvernement fédéral a jugé opportun de permettre aux entreprises, qui ont obtenu de bons résultats en 2022, d’accorder à leurs travailleurs une prime dite prime pouvoir d’achat, en 2023. Le gouvernement a laissé aux secteurs le soin de déterminer les critères d’attribution. Ainsi, les commissions paritaires 124 (ouvriers de la construction) et 200 (employés) ont fixé des conditions et des montants très différents. Lorsque nous écrivions ces lignes, les négociations au sein de la sous-commission paritaire des électriciens (CSP 149.01) sur l’octroi de la prime pouvoir d’achat n’avaient pas encore abouti.
Une prime pouvoir d’achat doit être accordée aux ouvriers de la CP 124 si l’entreprise réalise, en 2022, un bénéfice (code 9901 sur le compte annuel) supérieur d’au moins 15 % au bénéfice moyen de la période 2019-2021. Le montant de la prime dépend de l’excédent du bénéfice de 2022 par rapport à la moyenne de 2019-2021 : 250 € à partir de 15 %, 500 € à partir de 25 % et 750 € à partir de 50 %.
Pour le calcul de la moyenne, seules les années bénéficiaires sont prises en compte. Si une entreprise n’a réalisé un bénéfice qu’en 2019 et 2021, la moyenne est calculée en divisant le bénéfice de ces deux années par deux. Les
entreprises, qui ont enregistré des pertes en 2022, ne doivent pas payer de prime. Et s’il n’y a pas d’année bénéficiaire au cours de la période 2019-2021, aucune prime ne doit être versée, même si un bénéfice est enregistré en 2022. Pour les entreprises qui font partie d’une unité technique d’exploitation (UTE), les chiffres globaux de l’UTE sont pris en considération. La prime doit être accordée en décembre 2023 aux ouvriers en service au 1er décembre 2023 au prorata de leur nombre de jours de travail effectif en 2022 (nombre de jours de travail
Critères
Limitation
Niveau
Moyenne de calcul 3 ans
Exercice financier
≠ année civile
Montants
En service au
Période de référence
Au prorata
Primes d'entreprise déduites
CP 124
Bénéfice opérationnel
Max. 15 % du bénéfice 2022
UTE
Seulement les années avec bénéfice
Clôturé en 2022
250 (+15 %) / 500 (+25 %) / 750 (+50 %)
1/12/2023
1/1/2022-31/12/2022
Uniquement les jours travaillés
Oui
divisé par 219). La prime sera également « proratisée » si le total des primes à verser dépasse 15 % du bénéfice de 2022.
Pour accorder la prime pouvoir d’achat aux employés, il faut tenir compte du rapport entre le bénéfice et le total bilantaire. Une prime ne peut être accordée que si le bénéfice de 2022 représente au moins 5 % du total bilantaire. En outre, ce ratio doit être supérieur d’au moins 25 % à la moyenne de la période 2019-2021. Le montant de la prime dépend de l’augmentation du ratio en 2022 par rapport à la moyenne 20192021 : 125 € à partir de 25 %, 250 € à partir de 50 % et 375 € à partir de 100 %.
Pour le calcul de la moyenne, toutes les années de 2019 à 2021 sont prises en compte, y compris les années déficitaires. Seuls les chiffres au niveau de l’entité juridique sont pris en compte (c’est-à-dire aucun chiffre global de l’UTE).
La prime est payable au plus tard le 31 décembre 2023 aux employés en service au 31 octobre et ayant au moins un mois d’ancienneté à cette date. La prime sera calculée au prorata des prestations de travail pendant la période du 1er novembre 2022 au 31 octobre 2023. Les mêmes règles d’assimilation que pour l’attribution de la prime de fin d’année aux employés s’appliquent.
Les primes pouvoir d’achat doivent être
CP 200
Bénéfice opérationnel et ratio bénéfice/total bilantaire
Aucune
Entité juridique
Toutes les années
La plupart des mois en 2022
125 (+25 %) / 250 (+50 %) / 375 (+100 %)
31/10/2023 (min. 1 mois anc.)
1/11/2022-31/10/2023
Assimilations prime de fin d’année + corona
Oui
octroyées sous forme de chèques (électroniques ou papier). Les chèques sont valables jusqu’au 31 décembre 2024 et ne peuvent être utilisés que pour le paiement d’un repas ou pour l’achat de denrées alimentaires prêtes à l’emploi, ou pour l’achat de produits et services pouvant être payés avec des écochèques.
Les primes pouvoir d’achat sont exonérées d’impôt pour le travailleur. Pour l’employeur, elles sont déductibles à 100 %. L’employeur ne doit payer qu’une cotisation spéciale de l’ONSS de 16,5 % sur le montant des primes.
Les réductions accordées aux membres (réduction sur les frais administratifs) sont d’application lors de l’achat de chèques auprès des fournisseurs Edenred, Monizze et Sodexo.
Les entreprises peuvent également décider volontairement, à leur niveau, d’accorder une prime pouvoir d’achat si elles ont obtenu de bons résultats en 2022. Sur cette base, les entreprises peuvent accorder une prime même si elles ne remplissent pas les critères de la convention collective ou si elles souhaitent accorder un montant plus élevé. Cette prime doit être formalisée dans une convention collective d’entreprise ou dans des accords individuels avec les travailleurs concernés (Embuild a des modèles pour les membres). Toutefois, le total de la prime pouvoir d’achat accordée à un travailleur ne peut jamais dépasser 750 €.
Grâce, entre autres, à l’essor de l’assistance électrique, les vélos deviennent de plus en plus populaires, y compris pour les trajets domicile-travail. Nous connaissons déjà la voiture de société, et désormais le vélo de société fait son apparition. Mais qu’en est-il des indemnités kilométriques et autres ? Le service d’études d’Embuild reçoit beaucoup de questions à ce sujet actuellement. Nous répondons aux plus importantes d’entre elles.
Les questions typiques des membres sont les suivantes :
● Un vélo de société peut-il remplacer le salaire ?
● Une indemnité vélo peut-elle être versée ? Une indemnité vélo doit-elle être versée ?
● Quand un vélo d’entreprise donne-t-il lieu à un avantage en nature imposable ?

● Quels sont les coûts que l’employeur peut déduire des impôts ?
Mais tout d’abord, une autre question. Entre-temps, différentes mesures fiscales ont été prises pour encourager l’utilisation du vélo. Mais qu’est-ce qui est considéré comme un vélo, en matière fiscale ?
Le fisc utilise la définition du code de la route belge. Cette définition inclut les vélos classiques non électriques, les vélos de course, les VTT, les vélos de ville, les triporteurs et les vélos pliables, mais aussi les électriques et les speeds pedelecs. En outre, les tricycles, les vélos à bras et les autres vélos adaptés pour les personnes en situation de handicap sont considérés comme des vélos.
En revanche, ne sont pas considérés comme des vélos : les trottinettes électriques et non électriques, les hoverboards, les patins à roulettes, les skate boards, les monocycles et les Segways.
L’indemnité vélo est l’indemnité que l’employeur accorde aux membres du personnel qui effectuent tout ou partie de leurs trajets domicile-travail à vélo. Cette indemnité bénéficie d’un traitement très favorable du fisc et de la sécurité sociale.
Dans le secteur de la construction, la majorité des employeurs doivent verser une indemnité vélo. Cette obligation est d’ailleurs prévue dans les conventions collectives. Dans la CP 124, l’indemnité vélo obligatoire s’élève à 0,27 € par kilomètre effectivement parcouru. Ce montant est d’application depuis le 1er septembre 2023 ; auparavant, il était de 0,24 € par kilomètre. Dans la CP 200, l’indemnité vélo obligatoire est de 0,20 € par kilomètre, avec un maximum de 40 kilomètres par jour aller-retour. Le 1er juillet 2024, ce montant passera à 0,27 € par kilomètre.
Le travailleur ne doit pas payer d’impôts sur l’indemnité vélo tant qu’elle ne dépasse pas 0,27 € par kilomètre. Il s’agit du montant pour l’année des revenus 2023 (année d’imposition 2024). Il peut arriver qu'un employeur accorde une indemnité vélo supérieure à 0,27 € par kilomètre. Le travailleur paie alors des impôts sur le montant restant au-delà de ces 0,27 € comme sur un revenu professionnel.
L’indemnité vélo est aussi exonérée de cotisations sociales si elle ne dépasse pas le montant de 0,27 € par kilomètre. Cela vaut tant pour les cotisations de l’employeur que pour celles du travailleur.
Par ailleurs, le trajet en question ne doit pas nécessairement être le plus court. L’indemnité kilométrique pour un trajet légèrement plus long, mais plus sûr, peut également bénéficier de l’exonération d’impôt et de cotisations sociales.
L’indemnité vélo ne peut être accordée que pour les trajets effectivement parcourus à vélo. Celui qui se rend au travail à vélo en été et en voiture en hiver n’a droit à une indemnité vélo non imposable que pour les kilomètres effectivement parcourus à vélo en été.
Certains travailleurs se rendent à la gare à vélo pour prendre le train jusqu’à leur lieu de travail, ou combinent le vélo et les transports publics. Ils n’ont droit à une indemnité vélo que pour la partie du trajet qu’ils effectuent à vélo.
Pour attirer les travailleurs, les entreprises essaient d’offrir un package salarial attractif. Celui-ci comprend parfois une voiture de société, mais le vélo de société est également de plus en plus répandu.
Pour les ouvriers de la construction, la location d’un vélo sera plutôt exceptionnelle. En règle générale, les entreprises de construction paient leurs travailleurs selon les barèmes en vigueur et il n’est pas permis de convertir une partie de ce salaire en vélo de société.
Les travailleurs qui reçoivent un vélo de leur employeur bénéficient d’un avantage. Selon la situation, des cotisations de sécurité sociale et des impôts doivent être payés sur cet avantage. Il convient de faire les distinctions suivantes :
● Le travailleur utilise le vélo pour ses déplacements entre son domicile et son lieu de travail.
L’avantage du vélo de société est alors exonéré d’impôts et de sécurité sociale, même si le vélo est également utilisé pour des déplacements privés.
● Le travailleur n’utilise pas le vélo pour ses déplacements entre son domicile et son lieu de travail.
Dans ce cas, l’avantage est imposable et soumis à la sécurité sociale. L’employeur doit déclarer l’avantage sur la fiche de salaire 281.10.
Si le vélo de société est utilisé pour les déplacements domicile-travail, un certain nombre d’autres avantages sont exonérés de sécurité sociale et d’impôts : réparation gratuite du vélo ; service de dépannage gratuit ; kit de sécurité comprenant un casque de vélo, une veste fluorescente, des réflecteurs et des feux de vélo ; sacoches de vélo adaptées à un ordinateur portable et autres objets similaires appartenant à l’employeur.
Les vêtements de pluie sont soumis à des taxes et à des cotisations de sécurité sociale.
En 2023, un travailleur se rend chaque jour à son travail à vélo, à 8 kilomètres de son domicile. Il relève de la CP 200 et l’employeur est donc tenu de lui verser une indemnité vélo de 0,20 € par kilomètre.
Avec 220 jours de travail effectif par an, le travailleur recevra 220 x 8 x 2 x 0,20 = 704 € en 2023. Ce montant est exonéré de cotisations de sécurité sociale et le travailleur ne paie pas d’impôts sur ce montant. La totalité du montant est déductible auprès de l’employeur.
L’exonération d’impôts et de cotisations sociales pour un vélo de société se cumule avec l’indemnité vélo exonérée.
Les frais engagés spécifiquement pour encourager les déplacements à vélo sont déductibles fiscalement par l’employeur au titre de frais professionnels. Il peut s’agir, par exemple, de la construction d’un abri à vélos pour les membres du personnel ou de l’aménagement d’un vestiaire, avec ou sans douche. L’installation de panneaux solaires et de bornes de recharge pour les vélos électriques entrent également en ligne de compte.
Sont également déductibles les frais d’acquisition, d’entretien et de réparation des vélos et de leurs accessoires mis à la disposition des membres du personnel.
Parmi les accessoires de vélo, citons par exemple une pompe à vélo, une sonnette, de l’éclairage, des réflecteurs, une trousse à outils, une batterie…Les vêtements, en revanche, ne sont pas déductibles.
L’amortissement d’un vélo se fait par annuités fixes. Il doit y en avoir au moins trois.
L’usage professionnel et, par conséquent, l’étendue de la déduction de la TVA sont déterminés en fonction des circonstances réelles.
En tant qu’entrepreneur, vous ressentez très certainement la hausse des prix tous azimuts. Vous pouvez optimiser vos coûts, et cela concerne aussi vos assurances : un check-up régulier de vos couvertures permet de les adapter à vos véritables besoins et de détecter les doublons éventuels.
Les entreprises évoluent continuellement. D’où l’intérêt de procéder annuellement au contrôle de votre portefeuille d’assurances. Avez-vous élargi ou restreint le champ de vos activités ou engagé des nouveaux collaborateurs ? Vérifiez avec votre assureur si les garanties sont encore suffisantes ou s’il y a lieu de les revoir à la hausse ou à la baisse. Les primes que vous payez sontelles encore correctes ? Vérifiez par exemple s’il reste utile de souscrire une omnium pour un véhicule de cinq ans ou plus.

Même les assurances du dirigeant d’entreprise devraient idéalement être réexaminées au moins une fois par an. Un exemple : le revenu de remplacement prévu par votre couverture en cas de maladie ou invalidité estil encore suffisant ?
Cet examen annuel approfondi est indispensable pour éviter les mauvaises surprises. L’assureur qui connait bien son client et ses activités est en mesure d’agir proactivement et de cibler son aide.

Faites le
Le contrôle annuel de la situation de vos assurances peut également être l’occasion de regrouper certaines couvertures. Vous disposez ainsi d’un seul interlocuteur pour toutes vos assurances. En cas de besoin, vous savez donc exactement qui contacter. C’est plus facile et efficace.
Vous évitez en outre que certains risques ne soient pas couverts parce qu’ils passeraient entre les mailles du filet. Cela peut arriver si vous travaillez avec plusieurs compagnies d’assurances. En cas de regroupement, il est plus facile d’identifier les postes doublement assurés et la gestion administrative est plus aisée.
La prévention est une autre façon d’économiser de l’argent. Réduire le nombre d’accidents, par exemple du travail, a un impact financier : il n’y a pas de ralentissement de l’activité, pas de remplaçant à trouver, ... Cette approche s’inscrit également dans le processus de prise de conscience et de sensibilisation.
Le Risk Engineer de votre assureur peut vous aider à mettre en place une véritable culture de la sécurité sur le lieu de travail. Chez Fédérale Assurance, les conseils du Risk Engineer sont gratuits.
Comme vous pouvez le lire à la dernière page de ce numéro, malgré une récente diminution, il y a toujours plus de postes vacants dans le secteur qu’avant la crise sanitaire. C’est pourquoi les pénuries sur le marché du travail sont une priorité pour Embuild. Elles constituent une partie importante de notre cahier de revendications pour les partis politiques en vue des élections de 2024. Dans ce dossier, nous examinons sobrement le flux entrant et sortant du secteur, mais nous montrons aussi que la construction ne reste pas inactive. Nous nous efforçons de susciter l’intérêt des jeunes et des moins jeunes pour la construction. Nous comptons sur le soutien total du monde politique.

La société a un énorme besoin de travaux de construction, notamment pour préparer le pays aux défis climatiques. Nos entreprises peuvent les réaliser, mais elles doivent trouver la main-d’œuvre nécessaire. Le flux entrant doit donc être garanti.
Constructiv, l’organisme lié à la commission paritaire 124 des ouvriers de la construction, suit de près les entrées et les sorties dans notre secteur. Partant des données les plus récentes disponibles, un schéma est établi chaque année, permettant de comparer deux moments situés à précisément un an d’écart. La date choisie pour ce faire est le 30 juin.
Au 30 juin 2021, environ 140.600 ouvriers de la CP 124 travaillaient dans la construction. Un an plus tard, environ 2.000 d’entre eux avaient quitté le secteur pour cause de retraite ou une autre forme d’attrition naturelle. En outre, environ 16.700 ouvriers de la construction ont quitté le secteur pour d’autres raisons. Au total, 18.700 travailleurs ont donc quitté le secteur, ce qui représente un peu plus de 13 % de l’emploi.
Dans l’autre sens, un flux entrant d’environ 18.100 travailleurs a eu lieu. Les entrées ont donc été inférieures aux sorties.
Le flux sortant du secteur est sous-estimé par rapport au flux sortant des entreprises de construction. Environ 9.900 ouvriers ont rejoint un autre employeur du secteur de la construction en un an. Ils ont donc quitté leur entreprise mais sont restés dans la construction. Au total, environ 28.500 ouvriers de la construction ont quitté un entrepreneur. Cela représente plus de 20 % de l’emploi, un chiffre relativement élevé par rapport à d’autres secteurs.
Bien entendu, à plus long terme, une personne qui quitte le secteur n’est pas forcément perdue pour la construction. En effet, il y a aussi les « réentrants », qui reprennent du
service plus tard chez un entrepreneur. De plus, ces chiffres ne tiennent compte que des ouvriers de la CP 124. Les employés et les indépendants ne sont pas pris en compte.
Il ne faut donc pas paniquer, mais on peut tout de même conclure que, dans notre secteur, l’équilibre entre le flux entrant et sortant d’ouvriers est précaire. En outre, un autre problème se pose. La part des jeunes plus qualifiés dans les sorties du secteur est plus élevée que celle dans les entrées. Il existe donc un risque permanent de pénurie de travailleurs bien formés dans le secteur de la construction.
Enfin, si la tendance que nous venons d’esquisser se poursuit, il est tout simplement certain que la construction aura besoin de 90.000 à 100.000 personnes, réparties sur les cinq prochaines années, pour absorber le flux sortant du secteur. Et il ne s’agit là que des ouvriers de la CP 124.
Compte tenu de ce fait et de la mobilité de la main-d’œuvre au sein du secteur, il n’est pas surprenant qu’il y ait eu environ 14.000 postes vacants dans le secteur, juste avant les grandes vacances. Trouver des personnes adéquates pour ces postes est une énorme mission.
Ce sont surtout les petites entreprises qui ressentent les effets de la mobilité de la main-d’œuvre. Dans les entreprises de construction, comptant cinq travailleurs ou moins, environ 20 % ont quitté le secteur alors qu’un peu moins de 10 % ont été remplacés par un autre travailleur de la construction. Sur l’ensemble des ouvriers de la construction dans ces petites entreprises, un peu moins de 30 % ont donc quitté le secteur, ce qui est beaucoup plus que la moyenne sectorielle.
La relation entre la mobilité de la main-d’œuvre et l’âge est également intéressante. Le flux entrant avait connu un pic important entre 17 et 25 ans au cours de la période considérée. Le flux sortant a commencé à culminer à partir de 57 ans environ. Ceux deux phénomènes sont prévisibles : d’une part, les jeunes qui entrent dans le secteur et, d’autre part, les personnes qui partent à la retraite…
Mais les catégories d’âge les plus jeunes ne constituent pas seulement un pic dans les entrées. Elles sont également fortement représentées dans les départs des entreprises de construction. Il n’est donc pas facile pour les entrepreneurs de garder les jeunes qu’ils ont. Cela se voit dans la structure d’âge du secteur. La catégorie des 50-60 ans est plus fortement représentée que celle des 20-30 ans.
Constructiv ne se contente pas de collecter des données chiffrées, mais étudie également les raisons pour lesquelles les personnes quittent ou choisissent le secteur. L’enquête la plus récente date de novembre 2020 et a porté sur 19.000 ouvriers, répartis en cinq groupes cibles : les entrants, les sortants, les réentrants, les jeunes combinant travail et apprentissage et, enfin, le flux entrant durable.

Les réponses sont étonnamment uniformes au sein de ces groupes cibles. Les travailleurs rejoignent le secteur car ils peuvent travailler avec leurs mains, que le travail est varié, qu’ils veulent apprendre beaucoup et, enfin, parce que leur travail les rend fiers. Le pas vers la construction est d’ailleurs un choix délibéré. L’expression « je ne saurais pas quoi faire d’autre » a obtenu le score le plus bas dans l’enquête en tant que motivation pour venir dans le secteur.
Malheureusement, le fait que la construction offre désormais la possibilité de travailler avec l’automatisation, la numérisation et les nouvelles technologies à haut rendement énergétique est un autre élément de motivation qui a obtenu un score assez faible. Il semble que l’évolution technologique du secteur ne soit pas encore suffisamment connue ou appréciée. Il y a donc encore du travail à accomplir sur ce point.
Les ouvriers restent dans la construction en raison de la bonne rémunération, du
Une représentation schématique du flux entrant et sortant des ouvriers de la CP 124 dans le secteur.
contrat à durée indéterminée et de la bonne ambiance de travail. Les avantages sectoriels supplémentaires jouent également un rôle important dans la fidélisation au secteur.
Les motifs des personnes qui quittent le secteur sont principalement liés au développement personnel et au bien-être : elles ne se sentent plus bien dans leur travail, elles ne sont plus valorisées, la pression du travail est trop élevée ou elles veulent en apprendre davantage. Ainsi, quitter le secteur n’est pas immédiatement une question de bas salaire, de travail monotone ou d’herbe plus verte chez un autre employeur. Les ouvriers, qui ont de nombreux jours d’absence, sont plus susceptibles de connaître une rotation élevée de la main-d’œuvre, tout comme les ouvriers qui ne travaillent pas à temps plein.
Comme nous l’avons déjà indiqué dans cet article, les avantages sectoriels supplémentaires dont bénéficient les ouvriers sont très appréciés. Ils sont nombreux et concernent principalement le salaire et les conditions de travail : ancienneté, emplois de fin de carrière, crédit-temps, augmentation des barèmes… On peut le dire : les ouvriers de la construction jouissent d’un bon statut social. Décrire tous les avantages nous mè-
nerait trop loin, nous retiendrons donc deux exemples récents : les job coaches et l’extension de l’indemnité de promotion.
L’indemnité de promotion est un avantage financier que Constructiv a institué pour les ouvriers de la construction bénéficiant d’un prêt hypothécaire. La CCT 2023-2024 a augmenté le montant de cette prime. De plus, un ouvrier du secteur peut désormais également l’obtenir lorsqu’il contracte un prêt vert ou un prêt énergie.
Embuild a proposé de nommer des « job coaches » au niveau de Constructiv. Leur tâche principale serait de maintenir les ouvriers dans l’entreprise. Et en cas d’échec, au moins dans le secteur, éventuellement en tant que formateur.
Constructiv doit encore élaborer un plan d’action à cet effet, mais les grands principes semblent clairs. Les « job coaches » se concentreraient sur les groupes d’ouvriers qui connaissent le plus grand nombre de départs. Le travailleur et l’employeur pourraient tous deux faire appel au job coach. L’initiative doit venir d’eux, l’objectif n’étant pas que les job coaches fassent de la prospection.
Les partenaires sociaux de Constructiv soutiennent également l’enseignement, notamment en promouvant l’apprentissage en alternance, la forme de formation dans l’enseignement secondaire qui combine l’école et le lieu de travail.
Dans ce système, comme le jeune apprend le métier principalement dans l’entreprise, il reçoit une indemnité d’apprentissage. En outre, il (ou elle !) acquiert des congés payés et d’autres droits en matière de sécurité so-
VOUS FAITES QUELQUE CHOSE D’INTÉRESSANT POUR LES JEUNES ? FAITES-LE SAVOIR À NOS SPÉCIALISTES DES MÉDIAS SOCIAUX !
Embuild essaie également de susciter l’intérêt des jeunes pour un emploi dans la construction sur les médias sociaux. Nous sommes donc toujours à la recherche d’initiatives intéressantes à filmer et à diffuser. Vous faites quelque chose pour montrer aux jeunes à quel point un emploi dans la construction est passionnant ?
Faites-le savoir à nos spécialistes des médias sociaux ! Envoyez un e-mail à patrick.kulumbagies@embuild.be et wim.deloof@embuild.be
ciale. Mais en plus, Constructiv accorde des primes à ces apprentis en alternance. Toute personne, qui termine un apprentissage en alternance de trois ans et qui reste ensuite actif dans le secteur pendant au moins un an, recevra un total de plus de 2.000 € de primes. Actuellement, plus de 2.000 entreprises de construction différentes ont une agréation et disposent donc de places de stage pour former des élèves de l’enseignement secondaire. Ces entreprises ont également désigné plus de 2.500 mentors à cet effet.
Travailler dans la construction, c’est apprendre tout au long de sa vie. Le secteur dispose d’une offre de formations très large. Cela accroît son activité. Si vous avez récemment engagé un nouvel ouvrier, si l’un de vos ouvriers change de métier ou s’il souhaite simplement se perfectionner, Constructiv propose le trajet de maître-tuteur.
Il s’agit de 80 à 140 heures de formation sur mesure dans l’entreprise, réparties sur une année. L’ouvrier est formé par un tuteur, un travailleur formé de l’entreprise. Constructiv accompagne avant, pendant et après le trajet de maître-tuteur. Jusqu’à 140 heures, Constructiv apporte un soutien financier à la formation organisée. En outre, une prime de 1.000 € par maître-tuteur et par an est prévue.
Outre le trajet de maître-tuteur, il y aussi l’Emploi Tremplin Construction (ETC). Supposons que vous souhaitiez engager un ouvrier de moins de 27 ans, qui a mois d’un an d’expérience dans le secteur de la construction. Avec l’ETC, vous pouvez l’engager pour une durée indéterminée et le former en fonction de vos besoins et de ses compétences. Dans ce système également, l’ouvrier est guidé par un tuteur. Constructiv accompagne l’entreprise et bénéficie d’un soutien financier et de primes.
Il y a quelques années, Constructiv a mené une enquête auprès de plus de 2.000 Belges pour étudier l’image de la construction. Les résultats étaient décevants. Seul un Belge sur dix était enclin à travailler dans le secteur. Les chercheurs d’emploi étaient les moins positifs, mais les jeunes étaient également
Un flux entrant élevé chez les jeunes, un flux sortant élevé chez les personnes âgées. C’est logique, mais il faut noter que le flux sortant est également relativement élevé chez les trentenaires.
La proportion de flux entrant vers les petites entreprises de construction est élevée. Malheureusement, les petites entreprises sont également confrontées à un flux sortant relativement important.
critiques : à peine 11 % des étudiants envisageaient un emploi dans la construction.
Pour garantir la santé du secteur à long terme, les partenaires sociaux de Constructiv ont mis sur pied Nous construisons demain Cette campagne d’image vise à prouver à la société que la construction est un secteur diversifié, innovant et durable qui joue un rôle sociétal important. En outre, la campagne veut convaincre les jeunes et les chercheurs d’emploi d’étudier et de postuler pour un emploi dans la construction. Enfin, Nous construisons demain veut faire comprendre que nous avons la sécurité de l’emploi, des opportunités de carrière et des avantages supplémentaires à offrir.
Les ambitions sont donc grandes et, pour les réaliser, la campagne elle-même s’adresse à des publics cibles. Dans le numéro précédent d’Embuild Magazine, par exemple, vous avez
pu lire des informations sur les stands présents dans divers festivals de musique cet été.
En dehors de Constructiv, Embuild a également plusieurs initiatives qui peuvent intéresser les jeunes à un emploi dans le secteur. Tout d’abord, il y a notre célèbre Journée Chantiers ouverts, qui présente les meilleurs projets de nos membres. En Flandre, il y a aussi le Houtproef, qui existe désormais en deux versions, et qui donne aux apprentis l’occasion de montrer leurs compétences en tant que menuisiers. Embuild Vlaanderen a également lancé sa campagne #WerfZe pour attirer du monde dans le secteur. Dans ce dossier, nous développons également les différentes initiatives et les partenariats de nos entités régionales wallonne et bruxelloise pour rendre les emplois attractifs dans le secteur.
La construction wallonne a actuellement 6.000 à 7.000 postes vacants. C’est dire l’importance de rendre les jobs attractifs dans le secteur pour attirer des candidats. Embuild Wallonie et ses partenaires ont pris différentes initiatives à ce sujet. Présentation.
Sur la liste des métiers en pénurie que le Forem publie chaque année, on en retrouve plus de 40 liés à la construction. C’est inquiétant. Surtout quand on sait que pour réaliser les objectifs de rénovation énergétique du gouvernement wallon, le secteur aura besoin de milliers de travailleurs supplémentaires dans les prochaines années. On parle de 30.000 nouveaux professionnels d’ici 5 ans. L’emploi est l’une des principales préoccupations de nos entrepreneurs. Embuild Wallonie est bien consciente de ce problème structurel et aide ses membres à trouver du personnel qualifié. Au cours des dernières années, la fédération wallonne de la construction s’est engagée dans plusieurs projets visant à promouvoir les métiers de la construction.
Citons tout d’abord la campagne « Je construis mon avenir », lancée en 2019 à destination des jeunes de 15-25 ans, avec les partenaires sociaux, la Wallonie, le Forem et l’IFAPME. « Cette campagne a été lancée il y a quatre ans et poursuit sa route. Elle vient en complément à la campagne nationale de Constructiv « Nous construisons demain ». Elle se déroule principalement sur les réseaux sociaux et vise à redorer l’image des métiers techniques et manuels auprès des jeunes et des demandeurs d’emploi », explique GAUTHIER DE VOS , conseiller Emploi-Formation chez Embuild Wallonie.
Dans le cadre de cette initiative de promotion du secteur, le site internet www.jeconstruismonavenir.be a été créé. Il permet de chercher une formation, un métier, visualiser des témoignages inspirants, lire les 10 avantages des métiers de la construction ou encore poser des questions à une chatbox.
« Je construis mon avenir est une réussite ! Chaque année, plusieurs dizaines de milliers de visiteurs se rendent sur le site internet et montrent un engouement certain pour notre secteur », souligne Gauthier De Vos.
Autre initiative pour attirer de nouveaux talents dans le secteur : la série TV « Les Nouveaux Bâtisseurs ». « Elle s’inscrit dans le cadre du projet RENO+ et a été lancée par Embuild Wallonie, Buildwise et Greenwin. Il s’agit de cinq épisodes, mettant en lumière des acteurs engagés dans la construction et la rénovation énergétique, qui ont été diffusés durant l’été sur la RTBF. Ils sont encore visibles sur les réseaux sociaux et sur la plateforme Auvio. Chaque épisode revient sur les trajectoires de plusieurs personnes au sein du secteur et explique comment elles en sont arrivées là. L’objectif étant de donner l’envie de nous rejoindre à tous ceux qui regardent cette émission. », indique le conseiller Emploi-Formation.
La promotion, la communication… Embuild Wallonie collabore également avec l’enseignement supérieur pour attirer les hauts profils STEM. « Depuis quelques années, à la fin du mois de septembre, nous organisons des rencontres entre étudiants et entreprises, un speed dating construction. Cinq Hautes Ecoles sont partenaires : la Haute Ecole de la Province de Liège, la Haute Ecole Louvain en Hainaut
« Je construis mon avenir est une réussite ! Chaque année, plusieurs dizaines de milliers de visiteurs se rendent sur le site internet. »
(HELHa), la Haute Ecole en Hainaut (HEH), la Haute Ecole Robert Schuman à Arlon et l’ECAM. Il s’agit d’un partenariat avec Stages-up et Buildwise », explique Gauthier De Vos.
Notre entité régionale wallonne discute aussi beaucoup avec les autorités wallonnes pour résoudre le problème de pénurie de main-d’œuvre et attirer les talents dans le secteur. « Grâce à cette collaboration avec le gouvernement wallon, dans le cadre du plan de relance et de la reconstruction des zones sinistrées après inondations, deux mesures principales ont été prises », précise le conseiller d’Embuild Wallonie. « La première concerne l’octroi d’une prime de 2.000 € à celui ou celle qui se lance, au Forem ou à l’IFAPME, dans une formation aux métiers en pénurie de la construction, du bois ou de l’électricité. Cette prime s’étend sur la durée de la formation. Plus de 2.570 primes ont été versées aux apprenants IFAPME en 2022 », indique le conseiller d’Embuild.
La deuxième mesure concerne le Passeport Drive Construction. « Ils’agitd’unchèque permis de conduire décerné aux apprenants IFAPME des trois secteurs précédemment cités. Grâce à ce passeport, tous les frais liés à l’apprentissage du permis théorique et pratique pour voiture ou cyclomoteur sont remboursés. Cette mesure doit permettre de résoudre les problèmes liés à la mobilité des travailleurs. En effet, certaines personnes
souhaitent travailler sur chantier, mais n’ont pas les moyens de se déplacer. »

Enfin, soulignons encore les partenariats historiques entre Embuild Wallonie et l’IFAPME et le Forem. « Depuis des années, nous avons un partenariat privilégié avec l’IFAPME, qui est une voie royale pour rentrer dans le secteur. Cette filière de l’alternance, qui combine la théorie et le terrain, rend le secteur attractif et est très appréciée des entrepreneurs. De plus, son taux d’insertion à l’emploi de plus de 90 % est excellent. Avec le Forem, nous collaborons aussi bien au niveau régional, que provincial ou local avec des initiatives comme les jobdays, les opérations coups de poing pénurie qui proposent une formation sur mesure pour une entreprise particulière et des séances d’information. »
À n’en pas douter, la recherche de personnel est l’une de vos principales préoccupations. Après la lecture de cet article, vous comprenez qu’Embuild Wallonie multiplie les initiatives pour rendre les jobs attractifs et vous aider à attirer les talents qui construiront le monde de demain dans vos différentes entreprises. « L’emploi et la formation sont au cœur de nos priorités. Nous mettons tout en œuvre pour améliorer l’attractivité du secteur », conclut Gauthier De Vos.
"L'emploi et la formation sont au coeur de nos priorités. Nous mettons tout en oeuvre pour améliorer l'attractivité du secteur."
D’ici 2030, le secteur de la construction à Bruxelles aura besoin de 8.000 travailleurs supplémentaires, alors qu’il a déjà du mal à engager les 1.000 nouveaux entrants, nécessaires chaque année, pour maintenir son nombre de travailleurs. Nos collègues d’Embuild.Brussels sont impliqués dans plusieurs projets pour permettre à nos entreprises d’attirer des candidats. Voici un état des lieux avec Pierre Sturbois, coordinateur de la cellule Emploi-Formation.
Mentionnons d’abord cette campagne de communication qui a lieu dans le cadre de la stratégie Renolution (voir pp 30-31). « Embuild. Brussels est très impliquée dans ce projet. Et nous voyons déjà les effets de cette campagne. De plus en plus de gens se présentent aux séances d’information du mardi matin pour un emploi dans le secteur. C’est très encourageant et ça semble porter ses fruits », indique PIERRE STURBOIS
Notre entité régionale bruxelloise a également une personne dédiée qui s’occupe du « projet transition », pour veiller à la transition
durable des jeunes dans le secteur. « Elle travaille pour Embuild.Brussels, en partenariat avec Construcity. Sa mission est multiple et en termes d’attractivité, elle se déplace dans les écoles avec des options construction et plus principalement vers les apprenants en alternance de l’efp, pour vanter les mérites d’un métier dans le secteur : la bonne rémunération qui est encore assez méconnue, les nombreux avantages sociaux, les nombreuses possibilités d’évolution ou encore le fait que ces métiers se numérisent de plus en plus et sont porteurs de sens pour ceux qui les réalisent…Elle confirme à ces jeunes qu’ils ont réalisé le bon choix et répond à toutes leurs questions », explique le coordinateur.
Elle va également à la rencontre des entrepreneurs pour comprendre leurs besoins en main-d’œuvre. « Elle se déplace dans les entreprises, prend et traite leurs offres d’emploi ou de stage et les aide, en collaboration avec Construcity, à trouver le meilleur candidat possible. Dans le même temps, elle informe les entreprises des primes et subsides existants pour engager ou encadrer des stagiaires. S’y retrouver dans l’ensemble des primes et subsides disponibles est un exercice complexe et décourageant pour nos entrepreneurs. Bien souvent, les entreprises ne savent pas très bien ce à quoi elles ont droit et les démarches à réaliser à ce sujet. Cette personne fait également le lien entre les entreprises et l’efp, c’est-à-dire qu’elle trouve pour l’efp des entreprises qui désirent s’impliquer dans la formation des apprenants et qui finissent bien souvent par les engager. Pour faire connaître l’alternance aux entreprises, Embuild.Brussels organise aussi

les apéros de l’alternance, des événements qui leur permettent de découvrir le programme de formation, les ateliers de l’efp et les avantages de l’alternance. »
Construction Awards BXL
Depuis quelques années, Embuild.Brussels soutient aussi les Construction Awards BXL organisés par Constructiv. « C’est une excellente initiative qui vise à récompenser les élèves dans les options construction et mettre leur travail en avant. La dernière remise des prix a eu lieu à l’Atomium, au mois de juin dernier, en présence de ministres bruxellois. C’est une fierté pour les jeunes et leurs parents et des entreprises sont présentes au pied du podium pour proposer des contrats. »
Enfin, Embuild.Brussels est très impliquée dans le dossier du centre d’excellence construction : le Pôle Formation Emploi Construcity.brussels. Il doit constituer une véritable vitrine de la construction dans les années à
venir. « Pour attirer les jeunes, le secteur et ses partenaires publics nourrissent l’ambition commune d’ériger un centre de formation moderne et emblématique pour le PFE Construcity.brussels. Depuis des années, Embuild. Brussels se bat pour ériger ce centre d’excellence, répondant aux besoins du secteur et qui va contribuer à donner une image positive de ses différents métiers. Nous souhaitons faire de cet endroit un lieu où les jeunes ou ouvriers actifs pourront se former et échanger », indique Pierre Sturbois. « Un terrain, se situant à Berchem-Sainte-Agathe, a été acheté par le secteur et le permis a été accepté. Il y aura un mixte de rénovation d’un bâtiment déjà existant et de construction d’un nouveau. Beliris cofinance ce projet sectoriel. »
Puissent tous ces projets aboutir à un important flux entrant dans le secteur. Car, comme l’a déclaré LAURENT SCHILTZ , le secrétaire général d’Embuild.Brussels, lors du point presse organisé fin août à Construcity. « Tous nos métiers sont en pénurie et nous recrutons tout le monde ! ».
De bonnes chaussures de sécurité, bien ajustées à vos pieds et offrant un soutien suffisant, sont essentielles pour la santé de vos pieds et pour votre posture. Vos pieds vous portent toute la journée et c’est un travail difficile. C’est pourquoi il est important de porter de bonnes chaussures de sécurité pour soutenir vos pieds. Sievi est donc votre meilleur choix !



« De plus en plus de gens se présentent aux séances d’information du mardi matin pour un emploi dans le secteur. »
Le 5 septembre dernier, Embuild a visité le chantier du nouvel hôpital de Tournai (CHwapi), en compagnie de Thomas Dermine, le Secrétaire d’Etat pour la Relance et les investissements stratégiques. Notre CEO Niko Demeester a profité de l’occasion pour insister sur l’importance d’un plan d’investissements pour les années à venir. « Les investissements publics ne doivent pas diminuer après les élections de 2024, ils doivent atteindre les 4 % du PIB d’ici la fin de la prochaine législature en 2029 », a-t-il indiqué.

C’est sous un soleil de plomb que DIDIER DELVAL , directeur général du CHwapi, a accueilli les différentes délégations venues visiter ce chantier phare wallon, situé dans le centre-ville de la Cité aux Cinq Clochers. « L’architecture de ce site unique est liée à notre projet médical ambitieux, humain et pluridisciplinaire. Actuellement déployées sur trois sites à Tournai, les activités hospitalières de notre institution seront regroupées, à l’horizon 2026, sur ce site qui s’intègrera dans le Pôle de Santé Intégré en Wallonie picarde dont le rayonnement économique, social et environnemental sera palpable dans l’ensemble de la région de l’Eurométropole », a-t-il indiqué.
À n’en pas douter, le futur centre hospitalier « Union » est l’un des plus gros chantiers actuels en Wallonie. Quelques chiffres le prouvent. Il sera construit sur une surface de 150.000 m² avec 1.000 places disponibles dans un parking souterrain. Il accueillera 2.700 collaborateurs et disposera d’un quartier opératoire moderne avec 20 salles, un bassin d’hydrothérapie, un centre de conférences et un amphithéâtre extérieur intégré à un jardin. En tout, près de 800 lits seront disponibles pour les patients.
Le coût de ce projet de grande ampleur est estimé à 445 millions €, avec un subside de 220 millions accordés par la Région wallonne. Il est réalisé grâce à l’expertise et au savoir-faire de quatre entreprises membres d’Embuild, regroupées en association momentanée : Galère, Dherte, Tradeco et CIT Blaton. « En prenant part à des chantiers d’envergure, nous construisons des projets qui transformeront positivement l’avenir et l’usage des utilisateurs », a déclaré GIUSEPPE MOSCHITTA , directeur du projet chez Galère. « Notre région regorge de savoir-faire, mais le secteur de la construction fait face à une véritable pénurie de talents. Or la construction est un métier passionnant qui utilise les dernières technologies, grâce à l’intégration des modélisations 3D et de tous les moyens numériques disponibles. Il est donc essentiel de revaloriser les métiers techniques et d’améliorer leur formation et leur recyclage pour conserver notre savoir-faire. »
Local de l’étape, le siège de son entreprise étant situé à Flobecq, CHRISTOPHE CARDINAEL , l’administrateur délégué de Dherte, ne pouvait cacher sa fierté, lors de la visite. « Réaliser un tel projet avec trois partenaires wallons, c’est
« Réaliser un tel projet avec trois partenaires wallons, c'est impressionnant à tous points de vue. »Une belle délégation, emmenée par le directeur de l’hôpital Didier Delval (à g. sur la photo), a visité le chantier tournaisien.
impressionnant à tous points de vue. Oui, je suis très fier d’être là aujourd’hui. ».
STÉPHANE DELPIRE représentait l’entreprise Tradeco, basée à Mouscron, à quelques kilomètres de Tournai. « Cette visite est un événement pour nous. Nous sommes une société familiale et réaliser ce chantier, c’est rentrer dans la cour des grands », a-t-il indiqué.
MARC-ANDRÉ GENNART, le CEO de CIT Blaton, évoquait pour sa part « un projet iconique et complexe qui permet la synergie des compétences de chacun et qui contribue au développement de nouvelles infrastructures, basées sur la transition écologique, et à la création d’emplois dans le secteur de la construction et hospitalier ».
Ce projet est aussi la preuve que l’on investit dans les infrastructures de notre pays. Comme l’a expliqué THOMAS DERMINE , le Secrétaire d’Etat pour la Relance et les investissements stratégiques, qui a fait le point en matière d’investissements. « Je tiens tout d’abord à féliciter les quatre entreprises wallonnes pour ce chantier très impressionnant et intéressant de par sa conception. Il s’agit d’un seul projet situé en centre-ville, alors que d’habitude, ils sont réalisés dans la périphérie », a-t-il indiqué. « C’est la première fois qu’on a un Secrétaire d’Etat pour les investissements en Belgique. C’était nécessaire car depuis 40 ans, on sous-investit dans nos infrastructures, qui datent généralement d’avant les années 80. Le taux d’investissement est inférieur à 2,5 % du PIB depuis plus de 30 ans. La valeur de tous ces actifs se déprécie chaque année à cause de ce sous-investissement. Avec le démarrage du plan de relance, une nouvelle impulsion est donnée en matière d’investissements publics et l’objectif est d’atteindre 3,5 % du PIB à la fin 2024. Tous ensemble avec l’Union européenne et le fédéral, on va y arriver ! », a expliqué un Thomas Dermine, plein d’enthousiasme.
Il est ensuite revenu sur quelques projets du plan de relance, en pointant l’importance de notre secteur pour leur réalisation. « Ce plan est essentiellement un plan d’infrastructures puisque plus de 40 % des montants seront alloués à des projets de construction. Plus de 200.000 m² de bâtiments énergivores seront rénovés, plus de 78.000 bornes de recharge électrique seront installées et 1.390 km de pistes cyclables seront construites dans tout le

pays. Aucun plan d’investissements n’a jamais mis le secteur de la construction autant sous pression, alors qu’il souffre d’une pénurie de 18.000 à 20.000 équivalents temps plein, comme l’a rappelé Monsieur Moschitta. Les ouvriers de la construction sont les héros de la transition climatique et le gouvernement fédéral s’engage avec Embuild et ses partenaires dans la campagne d’image « Nous Construisons Demain ». On a déjà partagé avec Embuild un certain nombre de dossiers et d’autres défis sont à relancer avec le secteur de la construction. »
Niko Demeester
Ecoutant attentivement les propos du Secrétaire d’Etat, NIKO DEMEESTER a d’abord exprimé sa « satisfaction de voir des membres d’Embuild montrer leurs capacités et faire l’éloge du secteur avec un tel projet », avant de revenir sur le thème central du jour : les investissements publics. « Nos infrastructures sont obsolètes et ne répondent plus aux besoins de notre temps. Avec le lancement du plan de relance, les travaux d’infrastructure connaissent néanmoins une croissance de 4,7 % en 2023 et on prévoit également de la croissance en 2024. Nous travaillons à 200 % sur le segment de la construction le plus florissant, mais notre crainte est que ces investissements diminuent lors de la période post-électorale. Nous faisons donc ici appel à tous les pouvoirs publics pour qu’ils maintiennent le cap et prévoient un plan d’investissements pour les années à venir. Actuellement, on investit 2,7 % de notre PIB dans les travaux publics, soit beaucoup moins que les 3,5 % de nos pays voisins. L’objectif est d’atteindre 4 % du PIB, à la fin de la prochaine législature, en 2029. Pour combler tous les retards, deux législatures seront nécessaires. Il faudra passer de 13 milliards en 2021 à 25 milliards en 2034 », a expliqué le CEO d’Embuild.
« Il faudra passer de 13 milliards en 2021 à 25 milliards en 2034. »Le CEO d’Embuild, Niko Demeester (à g. sur la photo), et Thomas Dermine (à côté) ont fait le point sur les investissements publics après la visite.
À Bruxelles, la stratégie de rénovation du bâti Renolution est sur les rails depuis 2021. Depuis son lancement, les demandes de rénovation explosent. Et le secteur va devoir créer 8.000 emplois pour y répondre. Construcity. brussels, le Pôle Formation Emploi de la construction, pilote cette dynamique sectorielle, notamment via une campagne de communication (voir encadré). Le secteur et les politiques ont évoqué tous ces enjeux lors d’un point presse organisé au siège de Construcity, à Anderlecht.
Il y avait pas mal d’intérêt médiatique pour cette rencontre organisée, fin août, au cœur même de l’endroit phare, où l’on forme aux métiers de la construction à Bruxelles. Il faut dire que les sujets de la rénovation et de la pénurie de main-d’œuvre sont souvent relayés par la presse ces derniers temps. Et ils sont capitaux pour le secteur. Pour rappel, pour se conformer aux accords de Paris, la Région bruxelloise vise une moyenne de PEB C+ pour les habitations des particuliers d’ici 2050 et la neutralité carbone pour les bâtiments publics d’ici 2040. Il va donc falloir tripler le rythme des rénovations actuelles.
Un constat : les demandes de travaux et de primes augmentent, plus de 20 % pour ces dernières au premier trimestre 2023 par rapport à la même période en 2022. Désormais, il faut les bras. « Il n’y a pas que la demande, l’offre doit suivre. La campagne est un maillon essentiel de la stratégie Renolution, qui doit permettre de créer des milliers d’emplois dans le secteur de la construction. Pour y arriver, tous les acteurs publics et privés sont rassemblés et un gros travail est réalisé au sein de cette Alliance. La rénovation du bâti n’est pas qu’un enjeu social, elle est aussi une
opportunité économique. », a indiqué ALAIN MARON , le ministre bruxellois de la Transition climatique et de l’Energie.
Construcity.brussels met tout en œuvre pour former aux métiers de la construction et surtout, les valoriser. « Beaucoup de stéréotypes circulent encore sur ces métiers : pénibles, pas bien payés, fastidieux. Alors que c’est tout le contraire ! Les entreprises de construction innovent, le secteur de l’écoconstruction est très performant à Bruxelles, et le taux de rémunération est intéressant. Il est un peu en-dessous de la chimie. La stratégie de rénovation va susciter un surplus d’activités pour la construction qui s’en réjouit. Nous avons besoin de ce secteur, qui a une activité forte, et nous sommes ici réunis dans ce Pôle Formation Emploi, qui est notre meilleur outil régional pour former à ces métiers de la construction stables, durables, bien rémunérés et qui contribuent à nos objectifs climatiques. Construcity. brussels a formé environ 2.500 travailleurs et 1.000 chercheurs d’emploi en 2022. Nous voulons encore monter en puissance et renforcer cette belle dynamique »,

« Construcity. brussels a formé environ 2.500 travailleurs et 1.000 chercheurs d’emploi en 2022. Nous voulons encore monter en puissance et renforcer cette belle dynamique. »oLe point presse avait lieu au siège de Construcity, à Anderlecht.


Cette rencontre avec la presse était aussi l’occasion de rappeler les missions de Contrucity.brussels et de mettre le focus sur la campagne de communication, en partenariat avec Renolution et avec le soutien d’Actiris, Bruxelles Formation et la campagne « Nous Construisons Demain » de Constructiv, qui s’étale du 22 août au 30 septembre 2023. Elle vise à démontrer, aux jeunes principalement, les opportunités d’emploi dans des métiers porteurs de la rénovation durable et à mettre en valeur les formations liées à ces métiers.
Le Pôle Formation Emploi (PFE) de la construction a pour vocation de former, informer, sensibiliser et promouvoir le secteur de la construction bruxelloise. Avec le soutien des acteurs privés (Embuild et Constructiv) et publics (Actiris, Bruxelles Environnement, Bruxelles Formation et l’EFP/SFPME) de la Région de Bruxelles-Capitale.
4 AXES
Un discours politique agréable à entendre pour LAURENT SCHILTZ , le secrétaire général d’Embuild.Brussels et président de Construcity. Qui n’a d’ailleurs pas manqué de remercier le gouvernement pour ses investissements dans le secteur. « Renolution est un exemple de partenariat public- privé qui performe. Je voudrais remercier les ministres ici présents d’avoir choisi Construcity.brussels comme pilote de la stratégie de rénovation du bâti bruxellois. C’est un geste fort ! », a-t-il insisté. « 35.000 travailleurs exercent dans la construction à Bruxelles et environ 1.000 ouvriers entrent dans le secteur par an. Selon une étude de Bruxelles Environnement, Renolution va permettre de créer 8.000 emplois, notre souhait étant qu’ils soient durables et pourvus par des Bruxelloises et Bruxellois. Encore un chiffre intéressant, il y a 8.000 inscrits chez Actiris dans un cadre « construction ». Mais tous nos métiers sont en pénurie et nous recrutons tout le monde ! », a indiqué Laurent Schiltz.
INFO :
www.construcity.brussels info@construcity.be, 02/210.03.40 et dimitri.laenen@embuild.be , conseiller Emploi-Formation chez Embuild.Brussels.
Un accompagnement est proposé en travaillant donc sur ces 4 axes : l’emploi, la formation, la veille sectorielle et la promotion du secteur. « Nous accueillons tout le monde ici : des travailleurs, des chercheurs d’emploi, des élèves stagiaires, des formateurs et des enseignants qui testent et appréhendent des nouvelles techniques », a expliqué PHILIPPE VAN GINDERDEUREN , le directeur du PFE. « Notre porte d’entrée a lieu lors de séances hebdomadaires, qui ont lieu tous les mardis à 9h dans les locaux de Constructiv, à la rue Royale à Bruxelles. C’est là qu’on accueille un candidat intéressé par le secteur et qu’on l’oriente en fonction de ses besoins, via un entretien individuel et un accompagnement. Le succès de ces rencontres est grandissant. Alors que 750 personnes ont participé à ces séances en 2022, on en a déjà répertorié plus de 600 au premier semestre 2023. Grâce à sa collaboration avec Embuild.Brussels, Construcity est également un point de contact pour les entreprises qui peuvent faire parvenir leurs offres d’emploi. Nous traitons ces offres et assurons un matching avec des candidats motivés. »
La campagne est diffusée à l’aide de panneaux d’affichage dans les bouches de métro et dans les gares. Elle se décline aussi en version digitale avec des vidéos témoignages courtes et attractives sur YouTube et des influenceurs la boostent également. Une campagne « Les Femmes Construisent Demain » est aussi organisée, en parallèle et en collaboration avec « Nous Construisons Demain » de Constructiv, pour susciter l’intérêt de la gent féminine au secteur.
Enfin, depuis le mois d’avril 2023, huit vélos-remorques du Construcity Bike Show sillonnent les rues des 19 communes de Bruxelles et vont à la rencontre des citoyens dans des marchés, foires, festivals…Ils sont liés à un thème de la construction et permettent de faire connaître et tester les métiers porteurs de la rénovation durable et en pénurie. Cette initiative est l’un des lauréats de l’appel à projets Renolab ID « Plus de 1.000 personnes ont fait les animations sur ces vélos. On ressent un véritable enthousiasme », a souligné Phillipe Van Ginderdeuren.
Le Community Land Trust Bruxelles, en abrégé CLTB, est un opérateur privé agréé et reconnu par la Région de Bruxelles-Capitale, dont le but est de créer des logements abordables pour des ménages bruxellois à faibles revenus. Ce maître d’ouvrage achète les terrains, lance une procédure de marchés publics, où les entreprises soumissionnent, et suit le projet de la conception à la réalisation. Présentation.
«Les logements à Bruxelles sont inabordables ! ». Combien de fois n’avonsnous pas entendu cette phrase autour de nous ? Il est vrai que l’accès à la propriété n’est pas aisé à Bruxelles. C’est justement dans le but de trouver des solutions à cette crise du logement dans la capitale et créer des logements abordables que le Community Land Trust Bruxelles a été créé en 2012. Ce concept anglophone de scission du terrain et de la propriété est apparu dans les années 1960, en provenance du monde associatif aux Etats-Unis. Il devait permettre à la communauté afro-américaine d’avoir plus facilement accès aux logements.
Avant de faire des émules en Belgique (Gand et Louvain) et dans l’Union européenne (France, Pays-Bas et Allemagne), le CLTB est le premier à avoir vu le jour en Europe, il y a une dizaine d’années. « Notre objectif est triple : acheter les terrains où l’on va construire du logement social, ce qui représente une économie d’environ 20 % ; former les candidats-acquéreurs et accompagner ces candidats », explique THIBAULT LEROY, le co-directeur. « 40 % des Bruxellois répondent aux critères d’accès au logement social. Les personnes qui achètent des logements chez nous sont d’office propriétaires, il n’y a jamais de locataires dans nos biens. C’est très positif car ce sont des gens
motivés et qui s’engagent, dès le début, à vivre dans des logements durables et bien entretenus dans des quartiers agréables avec des liens qui se créent entre les habitants et le quartier. Nous voulons disposer des logements les plus qualitatifs possible », indique-t-il. « Nous nous adaptons aux moyens de nos candidats acquéreurs et le prix du logement reste plafonné dans le futur. Si un acquéreur a acheté un logement à 120.000 €, ce prix servira de base lors d’une éventuelle revente, très légèrement indexé. On s’assure que le logement garde sa valeur de base, ce qui représente une garantie pour le propriétaire. »

Le CLTB est une asbl et une fondation d’utilité publique. Son conseil d’administration est composé d’un tiers des propriétaires de ces logements, un tiers d’experts ou associations issus de la société civile et enfin un tiers de représentants de la Région Bruxelles-Capitale. Elle fonctionne effectivement, notamment grâce à des fonds publics. « Nous recevons des subsides de la Région bruxelloise pour financer une partie de nos opérations immobilières.
« S’engager avec nous, c’est construire des logements de qualité dans des conditions confortables à Bruxelles. »
↑ Les habitants et propriétaires, lors de la fête d’inauguration du projet Indépendance, à Molenbeek. Il se compose de 22 logements et a été réceptionné en 2022.

← La façade avant du projet Calico, à Forest. Il se compose de 34 logements et a été réceptionné en 2022.
Nos projets s’inscrivent dans des budgets de construction totale allant de 3 à 7 millions d’euros. Nous achetons aussi des terrains à des promoteurs. Intéressant à savoir : avec les charges d’urbanisme en Région bruxelloise, un promoteur d’un projet d’ampleur doit, soit payer une taxe, soit participer au développement de logement sociaux. Si le promoteur choisit de développer des logements sociaux, nous pouvons intervenir. Le fait que notre public soit des propriétaires peut rassurer et cela évite au promoteur de devoir payer des charges d’urbanisme », souligne le co-directeur.
Les différents projets du CLTB comportent de 5 à 20 ou 40 logements, il s’agit uniquement d’appartements. Depuis sa création, une grosse centaine de logements ont été réalisés via le CLTB, ce qui représente environ 20 logements par an. Beaucoup d’entre eux se situent le long du Canal de Bruxelles, à Molenbeek ou Anderlecht. « Notre objectif est d’augmenter à 30, 40…logements par an dans les prochaines années. Pour grandir, nous avons d’ailleurs créé la coopérative à finalité sociale Fair Ground Brussels il y a deux ans. Elle vise à lutter contre le sans-abrisme et permet ici aussi bien l’acquisitif que le locatif. En deux ans, nous avons construit une vingtaine de logements. Malgré tous ces projets, nous constatons que nous sommes encore trop peu connus par les entreprises de construction et les soumissionnaires sont parfois peu nombreux alors que nous sommes ouverts à toutes les entreprises belges, pas que bruxelloises. Les entre-
prises qui travaillent avec nous reviennent souvent, c’est la preuve que le concept leur plaît. Nous travaillons avec une équipe bilingue de 20 personnes, dont trois chargés de projets immobiliers. »
ANNA CHIAMBRETTO est l’une de ces chargés de projets immobiliers. Elle est en contact direct avec les entreprises et les candidats-acquéreurs. « Nous sommes l’interlocuteur unique de l’entreprise et de l’architecte au cours du chantier que nous suivons de très près. Chaque projet est unique et a ses spécificités, mais nous encourageons à la durabilité et à la circularité, comme le réemploi, quand c’est possible. Nous faisons également attention au tri des déchets sur chantier et aux nuisances pour le voisinage. Pour certains de nos projets, nous avons notamment demandé aux entreprises de signer une note de cadrage dans laquelle elles s’engagent à respecter certaines choses. Nous sommes aussi là pour aider les entreprises, par exemple en négociant des exonérations de taxes de voiries avec les communes où se situent les chantiers. »
Le CLTB accompagne également le citoyen qui acquiert le bien. « Nous visitons régulièrement le chantier avec le futur propriétaire, pour lui permettre de bien s’approprier son logement, répondre à ses questions…Nous sommes également présents entre la réception provisoire et définitive. Le logement doit être durable et facile à entretenir. Par exemple, nous privilégions l’installation de techniques spéciales pas trop compliquées », indique la chargée de projets immobiliers.
En guise de conclusion, Thibault Leroy avance trois arguments qui doivent vous encourager, chers membres, à travailler avec le CLTB. « Nous avons des nouveaux projets qui vont sortir de terre début 2024. S’engager avec nous, c’est construire des logements de qualité dans des conditions confortables à Bruxelles. Et enfin, nous nous assurons que le logement soit durable et que vous soyez le partenaire d’un projet innovant qui correspond aux besoins de la ville de demain. »
La preuve de tout cela ? Le Community Land Trust Bruxelles a reçu le prestigieux World Habitat Award, décerné par l’ONU, en 2021. Une belle reconnaissance, n’est-ce pas ?

Avec l’acquisition de l’entreprise Guisse & Fils (Villers-le-Bouillet), le Groupe Jean Nonet (Jemeppe-sur-Sambre) devient un véritable fleuron de la construction wallonne, en employant désormais 350 personnes, réparties sur six implantations en Wallonie. L’union a été signée fin août.
Deux entreprises familiales wallonnes ont donc décidé d’unir leurs forces : le Groupe Jean Nonet et l’entreprise Guisse & Fils.
Le Groupe Jean Nonet a été fondé en 1958 et est spécialisé dans les travaux de construction ou d’aménagement à l’extérieur des bâtiments : travaux de voirie, aménagements extérieurs, conduites et câbles enterrés, terrains de loisir et de sport, traitement et stabilisation de sols et démolition de génie civil et immeubles. Bien implantée dans la province de Namur, l’entreprise a notamment réalisé le site emblématique du Grognon, à Namur (espace Confluence) et son ancien CEO n’est autre que Jean-Jacques Nonet, l’ancien président de la CCW, désormais appelée Embuild Wallonie.
De son côté, l’entreprise Guisse & Fils possède plus de 45 ans d’expérience dans l’installation de clôtures et de solutions de contrôle d’accès. Elle s’est également spécialisée dans la mise en place de dispositifs de circuits de surveillance et de sécurisation de sites ainsi que de domotique. Parmi ses références emblématiques, l’entreprise a notamment travaillé pour Infrabel, La Défense, Liège Airport ou encore la Centrale nucléaire de Tihange.
Pourquoi cette union ? ANTOINE GUISSE , aux commandes depuis plus de 40 ans, remercie sa quarantaine de collaborateurs et ses clients de longue date, et explique les raisons. « Je n’avais pas d’héritier ni de successeur. Cette transmission assure la pérennité de
mon entreprise. Je suis convaincu qu’avec les équipes du Groupe Nonet, la poursuite de nos activités est assurée, en maintenant la qualité et l’ambiance familiale qui nous caractérisent », a-t-il indiqué.
Pour le Groupe Nonet, cette acquisition lui permet de compléter son offre de services et d’étendre son influence géographique. « J’ai pu travailler avec Antoine Guisse et ses équipes plusieurs fois au cours de ces dernières années. L’entreprise Guisse est sans conteste une référence du secteur et nous sommes fiers de pouvoir l’accueillir dans notre grande famille. Ils ont des compétences et des références impressionnantes qui vont sans aucun doute nous permettre de développer de belles synergies. Nos premiers contacts ont été très enthousiasmants et nous sommes ravis de poursuivre l’aventure avec les collaborateurs d’Antoine. Nous le remercions aussi de la confiance qu’il nous témoigne en nous léguant le travail de toute une vie », a pour sa part commenté SIMON NONET, l’administrateur délégué du Groupe Jean Nonet.
Le Groupe Nonet construit ses projets autour de quatre valeurs « REP’R » : Respect, Enthousiasme, Partenariat et Résultat. Il emploie désormais plus de 350 personnes réparties sur six implantations en Wallonie : Nonet (Jemeppe-sur-Sambre) ; Carrières & Terrassements, basée à Mons et active dans le secteur des impétrants depuis le début des années cinquante ; Hublet, active dans le recyclage des déchets de construction et concentrée sur le développement des services de ses centres de traitement agréés à Floreffe et Hour ; Signé Jean, entreprise qui se dédie depuis plus de 20 ans aux aménagements extérieurs pour les particuliers partout en Wallonie et à Bruxelles ; Namur Asphalte, basée à Perwez et spécialisée dans la pose d’enrobés et désormais Guisse & Fils.
Un incendie ou un accident dans votre entreprise, vos revenus en cas de maladie… Votre activité évolue sans cesse. Mais vos assurances… suivent-elles le rythme ? Contactez votre conseiller et faites ensemble le check-up assurances.

La recherche de talents sur le marché du travail deviendra un thème majeur pour notre secteur dans les années à venir. C’est ce que conclut Buildwise, l’ancien CSTC, dans une étude sur les tendances qui détermineront l’avenir de la construction.
Les évolutions dans le secteur se succèdent à un rythme effréné. Comment nos entreprises peuvent-elles y répondre ?
C’est en partie pour répondre à cette question cruciale que Buildwise (à l’époque le CSTC) a créé son Comité de vision, en 2019. Celui-ci a récemment réalisé une analyse approfondie des tendances, sous la direction du consultant KPMG. Les données recueillies ont permis de dégager d’importants points d’attention pour le secteur. Ils figurent dans le rapport Analyse de tendances et d’impact dans le secteur (belge) de la construction.
Le rapport identifie trois thèmes sur lesquels les entreprises de construction et d’installation devront se concentrer pour relever les défis : la numérisation, la durabilité et, enfin, l’investissement dans les collaborateurs et leurs compétences. Les deux premiers thèmes ont déjà été abordés dans les numéros précédents d’Embuild Magazine. Dans cette dernière publication de la série, nous nous penchons sur le troisième thème, la guerre des talents.
Selon le rapport, le secteur de la construction doit continuer à investir dans les compétences de ses collaborateurs pour rester résilient :
« La profession, le ‘métier’ de la construction est une constante évolution, cela se répercute également sur les compétences requises des entreprises de construction et d’installation. À cet égard, on observe des évolutions tant au niveau du type de compétences (soft skills, compétences numériques, etc.) que de la flexibilité et de la multidisciplinarité attendues de la part des collaborateurs. »
Mais nous n’avons pas besoin de vous le dire : il n’est pas facile aujourd’hui de trouver des personnes adéquates. C’est pourquoi notre secteur est lui aussi en proie à une guerre des talents.
Elle est perçue comme l’un des thèmes les plus urgents. C’est ce qui ressort d’une enquête menée par le Comité de vision auprès de 700 professionnels actifs dans la construction en Belgique. Selon le rapport, la maturité de nos entreprises est « moyenne » dans ce domaine. Mais outre ce facteur interne, il existe évidemment des facteurs environnementaux qui influencent le cours de la guerre des talents. Certains profils, dont le secteur a besoin, sont également très convoités par d’autres secteurs. Cela augmente le risque qu’un entrepreneur ne trouve pas les personnes adéquates pour certaines fonctions. Cela a pour effet de l’empêcher de réagir au changement et à l’innovation. Un autre facteur environnemental est le vieillissement de la population, qui réduit l’offre sur le marché du travail.
Le secteur belge de la construction ressent les effets de la tension sur le marché du travail. Selon certaines estimations, nos entrepreneurs souhaiteraient recruter environ 100.000 personnes dans les cinq prochaines années. Mais la tâche ne s’annonce pas simple. Depuis des années, le secteur est confronté à des difficultés structurelles pour trouver du personnel. Au début des Grandes vacances, on recensait plus de 14.000 postes vacants dans la construction. Selon une enquête récente d’Embuild, pour huit entreprises de construction sur dix, trouver du personnel est au moins un problème, voire un très gros problème. Selon le rapport du Comité de vision, deux facteurs entrent en ligne de compte :
« D’une part, le nombre de collaborateurs disponibles dans le secteur est insuffisant. De l’autre, l’engagement de personnes susceptibles d’occuper certaines fonctions ou disposant des compétences techniques nécessaires relève de plus en plus du défi pour les entreprises de la construction. »
Le rapport cite notamment les métiers de menuisier, de plombier, d’ingénieur en stabilité,

de chef d’équipe, de conducteur de chantier et de calculateur.

La demande de travailleurs qualifiés est donc supérieure à l’offre. Il y a plusieurs raisons à cela. Comme nous l’avons déjà souligné, il y a le vieillissement de la population, combiné au faible intérêt des jeunes talents pour une formation technique dans la construction.
Mais selon le rapport, il y a aussi « la complexité et la spécialisation croissantes des compétences techniques, qui génèrent un plus grand besoin de collaborateurs (dotés du bagage technique adéquat). » Le secteur est en constante innovation. De nouveaux matériaux, techniques et outils apparaissent constamment. Cela nécessite de plus en plus de connaissances qui doivent également être mises à jour.
« le secteur de la construction souffre d’un problème d’image et est souvent perçu comme ‘peu attractif’ par les nouveaux venus sur le marché du travail. Le secteur n’est pas toujours associé avec des perspectives d’emploi qualitatives en raison de problèmes liés à la santé ou la sécurité. Sur un marché du travail soumis à la concurrence, la qualité du travail prend de plus en plus d’importance quand il s’agit d’attirer du personnel qualifié et de le garder. L’équilibre travail-vie privée et le niveau d’autonomie (indépendance) constituent des facteurs importants à cet égard pour les travailleurs. »
Entre-temps, la guerre des talents qui a émergé signifie que « les coûts salariaux augmenteront pour l’entreprise de construction », selon le rapport.
De nos jours, les compétences techniques ne sont pas les seules à être importantes pour un travailleur dans la construction. Il existe également un besoin accru en compétences numériques et profils IT, en raison de la numérisation et de l’industrialisation des métiers dans le secteur (voir également la première mégatendance dont nous avons parlé dans Embuild Magazine de juin 2023). En outre, les compétences sociales deviennent de plus en plus importantes sur le chantier de construction, en partie à cause du nombre croissant de parties qui y travaillent : sous-traitants, fournisseurs…
En conséquence, la composition du marché du travail dans la construction évolue rapidement. Entre autres, les relations entre les différents groupes professionnels sont en train de changer. Les changements sur le marché du travail signifient également que la formation devra évoluer à l’avenant. Il paraît donc, par exemple, urgent de mettre davantage l’accent sur les compétences numériques et sociales dans les formations. En outre, la mutation rapide du secteur crée des défis non seulement pour la formation de débutants, mais aussi pour les travailleurs déjà en place. Ils devront, eux aussi, adapter leurs aptitudes et compétences aux nouveaux besoins. « Pour préparer le personnel à l’avenir, les entreprises doivent prévoir des formations permettant d’apprendre de nouvelles compétences et aptitudes. Le perfectionnement et le recyclage peuvent créer plus de sécurité d’emploi pour l’avenir », selon le rapport.
La technologie sauvera-t-elle le marché du travail de la construction ? Le rapport du Comité de vision présente une évaluation nuancée. La robotisation et la poursuite de l’industrialisation des processus de construction pourraient réduire les besoins en main-d’œuvre pour un certain nombre de métiers. Le rapport cite, par exemple, « les conducteurs de véhicules de service, magasiniers, ouvriers d’assemblage et les fonctions administratives. » Cela pourrait avoir un impact sur la guerre des talents.
Certains considèrent la robotisation comme une menace. Mais le rapport du Comité de vision se réfère au Forum économique mondial (World Economic Forum ou WEF). Celui-ci affirme que la robotisation créera plus d’emplois qu’elle n’en détruira. Un avantage supplémentaire est que les tâches physiquement pénibles, dangereuses et ennuyeuses peuvent être confiées à des robots. Le rapport note toutefois que toutes les tâches ne conviennent pas aux robots : « La robotisation sera envisagée différemment en fonction du fossé entre grands et petits acteurs : un menuisier exécutant de nombreuses tâches chez un petit entrepreneur est moins simple à remplacer par un robot qu’un menuisier travaillant à un endroit fixe et fabriquant chaque jour le même type de produits. C’est seulement au moment où les machines peuvent effectuer des tâches meilleur marché, plus rapidement et à un niveau de qualité analogue qu’elles deviennent plus intéressantes que le personnel humain. »
« Le secteur de la construction souffre d'un problème d'image et est souvent perçu comme 'peu attractif' par les nouveaux venus sur le marché du travail. »
rénover ne sont pas équipés d’un système de ventilation adapté ou n’en disposent pas du tout. La qualité de l’air intérieur y est souvent inadéquate et peut générer des problèmes d’humidité et/ou de santé.

L’Innovation Paper 41 de Buildwise vient ainsi à point nommé : il concerne, dans le contexte spécifique de la rénovation, la ventilation de base des logements individuels et des immeubles collectifs (équipés de systèmes de ventilation individuels ou d’un système de ventilation centralisé commun à plusieurs logements). La ventilation de base permet d’assurer aux occupants une qualité de l’air intérieur satisfaisante. L’Innovation Paper 41 s’intéresse aux systèmes innovants de ventilation à envisager en cas de rénovation de logements existants, dans le respect des exigences réglementaires.
Ce système de fenêtre de toit, dont le marché propose divers modèles, est limité à un espace et comporte une ou plusieurs fenêtres équipées d’une motorisation automatisée.
En Belgique, les logements à rénover sont légion. La rénovation permet d’adapter ces logements aux besoins de leurs occupants et aux défis posés par la transition énergétique. Dans ce contexte, la qualité de l’air intérieur d’un logement est un facteur essentiel sur le plan de la santé et du confort. Or, la plupart des logements existants et à
La ventilation des logements est couverte par la norme NBN D 50-001 à laquelle les réglementations PEB régionales se réfèrent et par la Note d’information technique n° 258 de Buildwise. Cette norme définit les quatre systèmes de ventilation classiques A, B, C et D (voir figure). Lors de travaux de rénova-
« Innovation Paper » : nouveau nom chez Buildwise pour ce qui était la « Monographie » du temps du CSTC. En l’occurrence, notre organisme sectoriel de recherche et d’innovation s’intéresse, dans l’Innovation Paper n° 41 tout récemment disponible sur www.buildwise.be, aux nouveaux systèmes de ventilation spécialement conçus pour les logements qu’on rénove…
tion, l’installation d’un système conforme à la norme belge n’est pas toujours simple, car certaines difficultés viennent souvent compliquer le projet, comme un manque d’espace pour les gaines et le groupe de ventilation d’un système mécanique (de type C et surtout de type D, par exemple) ou l’impossibilité d’installer des ouvertures d’alimentation naturelle dans le cas où les fenêtres ne sont pas remplacées (système C, par exemple). Le coût du système forme lui aussi un facteur déterminant vu que d’autres postes, tels que l’isolation de la maison ou le remplacement du système de chauffage, sont souvent à réaliser conjointement.
Fort complet, le document publié par Buildwise parcourt, sur 80 pages, les conceptions possibles en rénovation et ce qu’implique chacun des choix possibles en termes d’espaces et de débits, de régulation, d’ouvertures fonctionnelles, de sécurité incendie, etc.
Diverses fiches techniques complètent utilement l’ouvrage, depuis celles relatives aux « cascades » jusqu’à celle consacrée aux fenêtres automatisées.

Une série d’exemples d’application sont ensuite fournis, avec, in fine, toutes les annexes utiles.
Quatre systèmes de ventilation classiques issus de la norme NBN D 50-001.

● L’Innovation Paper 41 peut être téléchargé sur le site www.buildwise. be avec vos codes d’accès.
● Pour toutes informations
complémentaires : service Publications de Buildwise, Kleine Kloosterstraat 23, B-1932 Zaventem (tél. : 02/716.42.11, e-mail : publ@buildwise.be).
Buildwise a publié en juin dernier, sur une bonne quarantaine de pages largement illustrées et commentées, une Note d’information technique sur deux sujets connexes : la stabilité des terrains de construction pour les machines de fondation et le dimensionnement des plateformes de travail temporaires y relatives.

La NIT 287 a été élaborée par le groupe de travail « Géotechniques et travaux de terrassement » avec la supervision des ingénieurs-rapporteurs Nicolas Denies (Buildwise) et Noël Huybrechts (Buildwise) au sein du Comité technique « Gros œuvre et entreprise générale » de Buildwise et par le groupe de travail « Plateformes de travail » sous les auspices de l’Association Belge des Entrepreneurs de travaux de Fondation (ABEF - FEGC).
La reconnaissance du sol spécifique est le préambule indispensable au contrôle de la stabilité du terrain de construction. Elle s’effectue de façon phasée durant le prédimensionnement et le dimensionnement. La NIT 287 détaille cette procédure en y ajoutant la préparation du site.
La NIT 287 présente de nombreux schémas tels que celui-ci, montrant de quoi se compose une plateforme de travail.
Les exigences minimales pour le dimensionnement des plateformes de travail temporaires en Belgique sont ensuite passées en revue. Ce dimensionnement fait appel à diverses méthodes de calcul, expliquées dans la NIT 287. Il faut obligatoirement une « plateforme de travail ». Ce concept est également bien explicité dans la Note. La plateforme de travail temporaire se construit généralement en un matériau granulaire, tel que les granulats, recyclés ou non, utilisés en continu.
La Note d’information technique 287 vous fait ensuite entrer dans le monde des géosynthétiques en distinguant ceux qui sont de type « séparation » de ceux qui sont plutôt destinés à renforcer l’ensemble de la plateforme.
Les chapitres suivants de la NIT 287 sont consacrés à l’exécution, au contrôle de qualité, à l’adaptation, à l’entretien et à la répa-
ration, à l’évacuation de l’eau et au drainage, ainsi qu’à l’accessibilité des terrains de construction.

La Note d’information technique comporte enfin une annexe sur les méthodes de dimensionnement. En Belgique, le responsable du dimensionnement doit en effet choisir entre deux méthodes analytiques de dimensionnement : la méthode BRE BR470 et la méthode TWf. Pour faire ce choix, il devra tenir compte des exigences de son projet et de la pertinence de la quantification des tassements. Applicables uniquement sur terrain horizontal, ces deux méthodes, résumées dans un tableau synthétique en fin de NIT, peuvent généralement être utilisées pour vérifier la stabilité des terrains de construction pour les machines de fondation et pour dimensionner les plateformes de travail temporaires.
La NIT évoque enfin la détermination des charges, les pressions de contact et les facteurs de sécurité ou facteurs partiels.

Au total, 165.000 m³ de déblais ont été évacués par la route vers l’un des sites récepteurs agréés d’eloy.
Le problème de stationnement est récurrent depuis des années aux alentours du CHU de Liège, sur le site du Sart Tilman. Avec la construction de trois nouveaux parkings, triplant presque la capacité d’accueil de véhicules, ce problème est désormais résolu après environ trois ans de travaux. Embuild Magazine a visité le site, avec notre membre eloy, la cheville ouvrière de ce projet.
Sur les hauteurs du sud la Cité Ardente, le site du Sart Tilman est connu pour y accueillir, entre autres, l’Université de Liège ainsi que le CHU. Vous pouvez l’imaginer, il est fort fréquenté au quotidien. Si l’université et l’hôpital ont leurs parkings respectifs, le centre hospitalier souffrait d’un manque criant de places. À la suite du constat de l’inadéquation de l’offre de parkings par rapport aux besoins, le CHU a lancé un marché de concession ayant pour double objectif de passer le nombre de places disponibles de 1036 à 2.828, tout en maintenant l’activité hospi-
talière et académique durant la période des travaux.
Ce contrat, c’est le consortium 6nergy Park qui l’a remporté. Il regroupe les entrepreneurs eloy et Democo, les architectes Herbiet & Grosch Architectes et l’Atelier d’Architecture du Sart Tilman, le bureau d’études Lemaire Ingénieurs, la société SEMACO pour la planification et coordination du chantier, le bureau de contrôle SECO et l’exploitant Optimal Parking Control.

Le contrat, attribué fin 2019, est de type DBFMO (Design-Build-Finance-Maintain-Operate) pour une durée de 30 ans. Il s’agit d’une première pour notre membre sprimontois. « En tant qu’acteur local bien implanté dans la région de Liège, il nous tenait à cœur de remporter ce marché. Nous étions l’outsider et nous l’avons finalement obtenu. Nous avions déjà construit les parkings du CHU à Esneux et avions parfaitement compris la philosophie de ce projet », indique CÉDRIC NILS , responsable Design & Build chez eloy. « Les défis étaient nombreux sur le site :
maintien d’une capacité minimale de parking durant la durée des travaux, maintien de l’accès des véhicules d’urgence, maintien du transport médical héliporté et parvenir à combiner les surfaces mises à disposition, les contraintes de niveau et la contenance minimale imposée de chaque parking », explique Cédric Nils.
La visite commence par le P112, qui est situé en contrebas du site, au niveau des urgences et de l’entrée du personnel. eloy a assuré l’intégralité de la construction de ce parking pour le faire passer d’un seul niveau (240 places de plain-pied), au sommet du talus, à cinq niveaux (1.229 places disponibles), sur 13 mètres de hauteur. « La principale contrainte était de travailler sur une surface réduite tout en maintenant le talus en place, dans un environnement, comme vous le constatez, très boisé. Il fallait que ce parking s’intègre parfaitement dans le paysage assez verdoyant qui l’entoure », indique le responsable Design & Build. « Après le déblai de milliers de m³ de terres, il a fallu maintenir les contours du site avec des parois gunitées clouées. Ce sont des parois en béton projeté, armées d’un treillis et ancrées dans le sol et les murs via des clous. Elles permettent de renforcer le sol et retenir les terres. Après cette phase, la construction du parking commence. C’est du classique avec des colonnes, poutres en béton et hourdis précontraints avec des chapes de compression. Nous avons également fait placer de la résine polyuréthane, appelée résine PU et de la résine PMMA pour le dernier niveau, ce que l’on pose

généralement sur les sols de parking pour garantir l’étanchéité et éviter les fissures », explique Cédric Nils.
Ce parking est relié à l’Avenue d’Hippocrate par une double passerelle, une pour l’accès et l’autre pour la sortie. Et, comme déjà indiqué, l’héliport a dû être déplacé.

« C’est l’une des forces du CHU, qui devait rester accessible en hélicoptère durant la durée des travaux. Nous l’avons donc déplacé d’une trentaine de mètres en un temps record. Une autre difficulté, tout au long du chantier P112, était également de « cohabiter » avec l’héliport. Effectivement, avec les engins de levage, par exemple, il fallait tenir compte des couloirs aériens. »
Sur ce site, évoquons aussi les surfaces différentes des niveaux pour donner un effet « escalier » à l’ensemble du bloc. « C’est voulu pour adoucir le volume dans le paysage, de même que l’acier corten qui ressort un peu partout pour donner un aspect naturel. Une toiture végétale a également été installée. »
Après le 112, place au P109, qui se situe un peu plus haut, juste devant l’entrée de l’hôpital. Il comporte deux niveaux réservés aux PMR et est passé de 64 à 494 places avec également un rez-de-chaussée + 4 niveaux comme le P112.
Enfin, le dernier, le P101, situé au-delà du 109, est le dernier à avoir été terminé. Il a été inauguré début octobre. Sa capacité est passée de 732 à 1105 places avec un rez-de-chaussée + 2 niveaux.
Sur ces deux parkings, c’est le partenaire d’eloy, Democo, qui a réalisé la
« Nous montrons aux acteurs du secteur de la construction que nous sommes une entreprise sérieuse et ouverte à d’autres projets de grande ampleur dans le futur. »
↑ Le P101 est le dernier à avoir été terminé. Il a été inauguré au début du mois d’octobre.
partie hors-sol, eloy prenant à son compte les terrassements, l’égouttage et les aménagements extérieurs. « Ce sont les mêmes techniques qui ont été utilisées pour les trois chantiers. Tous les parkings représentent une surface de 85.000 m², dont 17.800 m² de surface au sol », précise Cédric Nils. « Au total, les travaux, ce sont 165.000 m³ de déblais évacués par la route vers l’un de nos sites récepteurs agréés ; 4.640 m² de parois gunitées clouées ; 63.500 m² de hourdis ; 65.900 m² de résine PU et 17.800 m² de résine PMMA. »

Les trois parkings du CHU sont désormais opérationnels. Pour la plus grande fierté de Cédric Nils. « Au départ, ça ressemblait à une mission impossible. Mais quand notre administrateur délégué est venu me voir en me disant « Cédric, je veux le dossier des parkings du CHU », nous avons su monter une équipe capable de réaliser une telle prouesse. Il s’agissait d’un projet à la fois nouveau et grandiose pour l’entreprise, et nous l’avons réalisé en tenant le coup sur la durée ; malgré la crise sanitaire, les pénuries de matériaux et l’explosion des prix. Les équipes y ont pris plaisir à travailler et le résultat final est qualitativement une belle réussite », conclut le responsable Design & Build d’eloy.
Photos: © eloy
DAVID ELOY, l’administrateur délégué du groupe eloy, n’hésite pas à parler « du projet le plus ambitieux en termes de volume », lorsqu’il évoque ce chantier. « Nous n’avions jamais réalisé de parking d’une telle ampleur. Nous avons pu compenser notre jeunesse dans ce dossier par l’ingéniosité, la capacité et la disponibilité des équipes à mener à bien un projet pour un partenaire historique comme le CHU, heureux de travailler avec un acteur local. Nous devions franchir un palier et nous l’avons fait. Nous montrons aux acteurs du secteur de la construction que nous sommes une entreprise sérieuse et ouverte à d’autres projets de grande ampleur dans le futur », souligne David Eloy. « Mes collaborateurs habitent généralement dans la région de Liège et vont pouvoir s’identifier à ce chantier de l’hôpital, qui parle à tout le monde. Nous sommes très fiers ! ».
nouveau format




Avec PLS Newton, donnez de la hauteur à votre projet.
1. Résistance accrue à la compression


















2. Tous les avantages du bloc Porotherm PLS, pour travailler avec du mortier-colle ou avec le système Dryfix (ATG)

3. La solution de construction en terre cuite par excellence pour les immeubles à appartements et constructions utilitaires























www.wienerberger.be/fr/plsnewton

Il arrive que le maître d'ouvrage vous demande d'effectuer des travaux supplémentaires sur le chantier même. Il vaut toujours mieux dans ce cas disposer d'un bon de commande écrit.
Embuild édite un petit carnet pratique de bons de commande en papier autocopiant que vous pouvez immédiatement utiliser pour noter les travaux supplémentaires qui vous sont demandés. Ces formulaires incluent aussi les mentions nécessaires concernant le délai d'exécution, les prix, ... Une fois complété, vous pouvez remettre directement sur place une copie à l'architecte et au maître d'ouvrage.
Ce carnet très pratique ne coûte que 8,00 € la pièce (pour les membres de Embuild) ou 15,00 € (pour les non-membres).
PROMOTIE (enkel voor de leden): 5 exemplaren = 35,00 € (prijzen exclusief BTW)
Prix de vente spécial – seulement pour le mois d’octobre 2023
Prix membres pour cet ouvrage: 8,00 € htva
Prix non-membres pour cet ouvrage: 15,00 € htva
Cette publication peut être commandée en envoyant un mail à commandes@embuild.be

Embuild Magazine est le mensuel de l’asbl Embuild Avenue des Arts 20, 1000 Bruxelles
Editeur responsable : Filip Coveliers, Avenue des Arts 20, 1000 Bruxelles.
Bureau de dépôt : Gent X
Rédaction :
• Edition francophone : marc.gueret@embuild.be
tél. 02 545 57 31
• Edition néerlandophone : peter.graller@embuild.be
Mise en page : abder-razzaaq.boujdaini@embuild.be nikka.cuypers@embuild.be
Secrétariat de rédaction : secretariatredaction@embuild.be
Impression : Graphius
Réactions-questions : communication@cembuild.be
Avec la collaboration des services d’études de :
• Embuild morgane.halleux@embuild.be tél.02 545 56 33 • fax 02 545 59 09
• Embuild Wallonie katia.bogaard@embuild.be tél. 02 545 56 75 • fax 02 545 59 05
• Embuild Vlaanderen johan.walewijns@embuild.be tél. 02 545 57 49 • fax 02 545 59 07
• Embuild Bruxelles-Capitale morgane.cendoya@embuild.be
tél. 02 545 58 29 • fax 02 545 59 06
Abonnements : claude.bernaerts@embuild.be
tél. 02 545 56 88 • fax 02 545 59 00
Publicité : kristel.dekempeneer@embuild.be
tél. 02 545 56 99 • fax 02 545 59 08,
Prix abonnement annuel
• Membres d'Embuild: compris dans la cotisation
• Non-membres : 137,80 euros (TVA et frais de port compris)
• Etranger : 300 euros (TVA et frais de port compris)
Vot re mensuel Construction est dorénavant imprimé sur du papier issu de la gestion durable des forêts. Le label Forest Stewardship Council veille à la préservation de l’écosystème forestier ainsi qu’au respect des droits sociaux des populations indigènes et des travailleurs forestiers.
Pourquoi des chaussures de sécurité ne devraient-elles pas être confortables?

Agréablement souples et ergonomiques, tout en satisfaisant aux normes de qualité les plus sévères, voilà ce que proposent les chaussures uniques de Sievi!
Les articles Sievi sont des produits de première qualité, fabriqués en Finlande, entièrement à la main, et sont continuellement améliorés grâce à l’innovation et à la recherche.
www.sievi.com

Réduction membre:
Pour plus d'informations sur les remises accordées aux membres, contactez Sievi. Nous orienterons alors les clients vers le meilleur point de distribution à proximité.

Contact:
Bob Brems
T + 32 14 73 50 75
Bob.Brems@sievi.com


Un entrepreneur membre d’Embuild - l’ex-Confédération
Construction – peut dormir sur ses deux oreilles. Il ne trouvera pas de meilleur partenaire pour :





• Être conseillé



• Être informé


• Être soutenu



• Voir ses intérêts défendus





• Réseauter

• Promouvoir son entreprise auprès du grand public entre autres via buildyourhome.be

Devenez membre sur embuild.be/fr/devenir-membre

Est-ce que tous vos véhicules disposent de l’équipement nécessaire ? Si vous cherchez toujours la réponse à cette question, vous aurez besoin d’ABAX Smart Inventory. ABAX a récemment lancé ce système de suivi des stocks et a immédiatement reçu un prix de l'innovation.
ABAX Smart Inventory donne un aperçu en temps réel de l'équipement de votre flotte. Ainsi, vous pouvez être sûr que les véhicules sont suffisamment équipés pour les prochains travaux. S’il manque quelque chose, les chauffeurs et les opérateurs reçoivent une notification dans les minutes qui suivent leur départ. Cela leur permet de récupérer rapidement le matériel et de minimiser les pertes de temps. Et cela s'avère payant car, par exemple, le

fait de devoir revenir en voiture pour récupérer du matériel abandonné peut coûter des dizaines de milliers d'euros par an à une grande entreprise, selon ABAX.
Si cette solution peut se montrer avantageuse pour le secteur de la construction, le système est également déjà testé par des
hôpitaux, entre autres, pour s'assurer que les ambulances sont bien équipées et que les équipements de sauvetage ne manquent pas. ABAX Smart Inventory est pratique pour tous les secteurs ayant des flottes équipées de matériel de valeur.
INFO : www.abax.com


Les plafonneurs, les carreleurs et les façadiers peuvent désormais travailler avec Knauf Tools, une nouvelle gamme d’outils pour pratiquement tous les projets de construction Knauf. La gamme, présentée lors des Knauf Discovery Days en septembre 2022, est désormais déployée dans son intégralité. Knauf est surtout connu dans le secteur de la construction pour ses plâtres, ses plaques de plâtre et ses isolants. Avec Knauf Tools, elle propose désormais les outils adéquats pour appliquer ces produits de la meilleure manière possible, explique Mathilde Gruslin, Retail Market Manager. « Poncer, jointoyer, enduire, badigeonner, chaperonner... pour presque chaque phase, il existe désormais un outil spécifique pour optimiser les propriétés du produit. De plus, les outils sont ergonomiques, ce qui vous évite des efforts et des
contraintes inutiles. »
La gamme complète d'outils Knauf fait au total près de cinq mètres. Des règles aux peignes ou des hachettes de plâtriers, en passant par les éponges, sans oublier tous les
couteaux nécessaires, les planches à poncer, les truelles…Les commerçants peuvent faire leur sélection pour ainsi créer leur propre espace à outils.
INFO : knauf.be/fr/knauf-tools-pro

La La huitième édition du championnat européen des métiers techniques et technologiques s’est déroulée à Gdansk (Pologne), au mois de septembre dernier. L’équipe des Belgian Red Bears représentait la Belgique lors de cette compétition dénommée EuroSkills Gdansk. Parmi les 24 Belges engagés dans 19 métiers, cinq concouraient dans des professions liées au secteur de la construction.
En menuiserie, Alain Maes (Melen) a obtenu une médaille d’excellence, une cotation égale ou supérieure à la médiane, soit un résultat de valeur mondiale. Pascal Krott (Eupen) et Dean Theis (Rocherath) ont participé au concours en aménagement des parcs et jardins ; Santino Nika (Limbourg) en maçonnerie et Tom Heinrichs (Eupen) en sani-chauffage.
Embuild Wallonie félicite tous ces candidats et soutient WorldSkills Belgium. Il s’agit de l’association belge en charge de la promotion des métiers techniques et technologiques, notamment par le biais de compétitions de haut niveau organisées chaque année en Belgique,
les Startech’s. WorldSkills Belgium est le représentant en Belgique de World Skills International (l’organisation mon diale, 85 pays membres) et WorldSkills Europe (l’organisation européenne, 32 pays membres).
5,6 %
↑ ↑ Les 24 candidats belges qui ont participé à l’EuroSkills Gdansk.

↑ La « team construction ». De g. à dr. : Alain Maes, Santino Nika, Tom Heinrichs, Pascal Krott et Dean Theis.
Selon l’enquête trimestrielle du SPF Economie, 15.300 offres d’emploi étaient disponibles dans le secteur de la construction au deuxième trimestre de cette année. Un an plus tôt, à la même période, 16.200 postes étaient vacants. Il s’agit d’une baisse de 5,6 % par rapport au deuxième trimestre 2022, mais ce nombre dépasse toujours de 25 % le nombre d’offres d’emploi (12.200) proposées avant la crise du coronavirus au cours du premier trimestre 2020. Dans l’ensemble de l’économie, le nombre d’offres d’emploi a également diminué de 8,8 % (195.000) au deuxième trimestre 2023, par rapport à la même période en 2022, où 213.800 offres d’emploi étaient proposées dans l’ensemble de l’économie.
Le salon professionnel belge dédié aux techniques d'installation : climat intérieur, installations sanitaires, électrotechnique, automatisation et sécurisation, chauffage, ramonage et traitement d’eau
Dans les grandes salles du Brussels Kart Expo, de 9h00 à 19h00.
Accès gratuit pour les professionnels de la construction.
Ambiance et convivialité assurées grâce à des buffets gratuits et des boissons.
organisation:
Embuild THE BELGIAN CONSTRUCTION ASSOCIATION
une initiative de: partenaire médiatique:
Techlink by Techlink by Techlink by Techlink
Le salon professionnel et l’événement de réseautage de l’année pour les fabricants, prescripteurs, architectes et spécialistes dans le domaine du parachèvement : peintres, menuisiers, vitriers, poseurs de plafonds et cloisons, plafonneurs, parqueteurs, carreleurs et poseurs de mosaïques,…
Dans les halls spacieux de Brussels Kart Expo à Grand-Bigard de 9h00 jusqu’à 19h00.
Accès gratuit à plus de 160 stands.
Ambiance conviviale avec boissons et buffets gratuits.
organisation: une initiative de:
initiative : organisation :
Le salon professionnel et l’événement de réseautage par excellence au Benelux pour les couvreurs, entrepreneurs d’étanchéité, fabricants, architectes, prescripteurs et professions du secteur de la toiture...
Dans les halls spacieux du Brussels Kart Expo de 9h00 à 19h00.
Accès gratuit à plus de 140 stands.
Ambiance conviviale avec boissons et buffets gratuits.
Belgium

